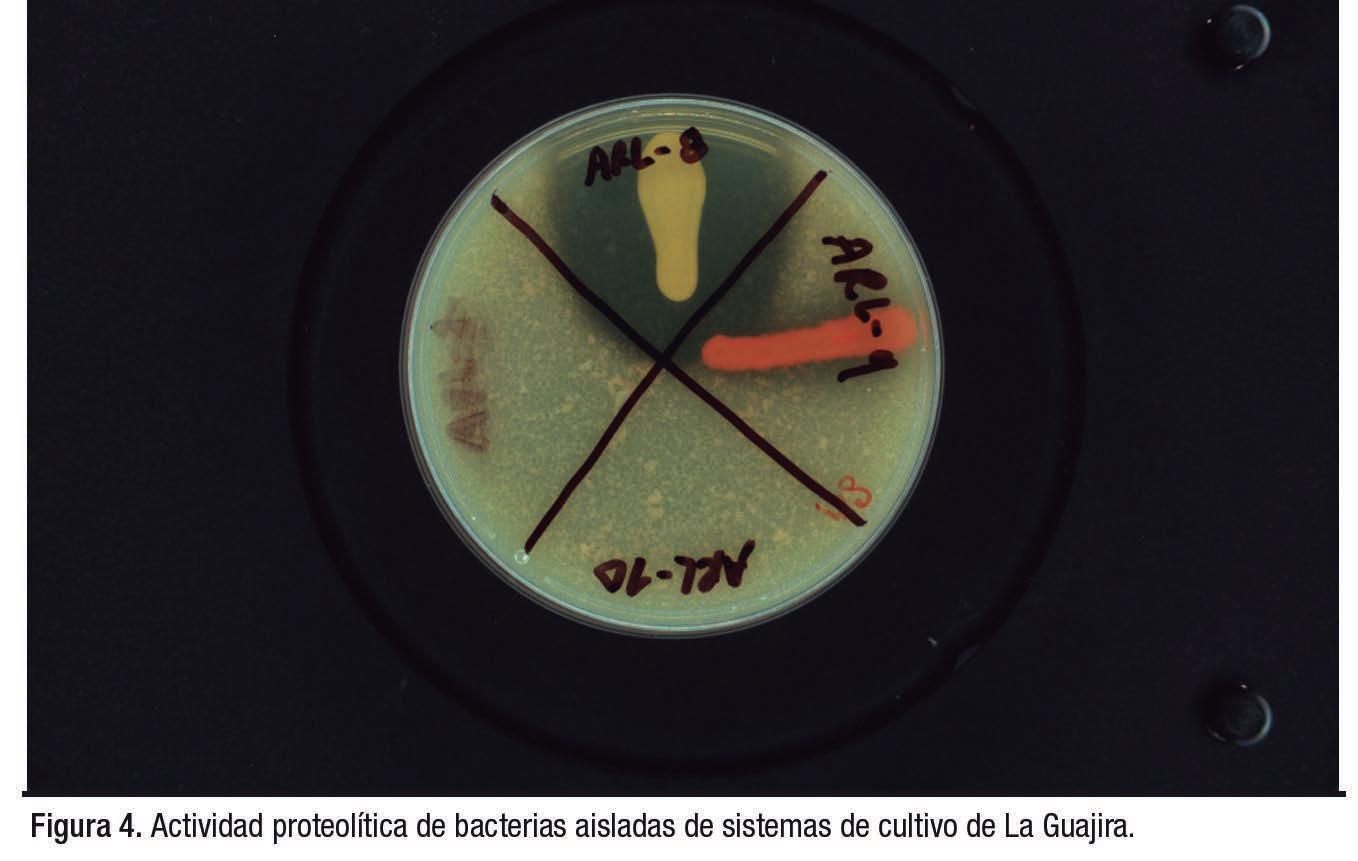

DIRECTOR Salvador Meza info@dpinternationalinc.com
EDITOR ASOCIADO
Marco Linné Unzueta
COORDINADORA EDITORIAL Karelys Osta edicion@dpinternationalinc.com
DIRECCIÓN ADMINISTRATIVA
Adriana Zayas Amezcua administracion@dpinternationalinc.com

COORDINACIÓN DE OPERACIONES
Johana Freire opm@dpinternationalinc.com
COLABORADORES EDITORIALES
Carlos Rangel Dávalos
DISEÑO EDITORIAL / PUBLICITARIO Perla Neri design@dpinternationalinc.com
VENTAS Y MARKETING crm@dpinternationalinc.com
CIRCULACIÓN Y SUSCRIPCIONES Renée Meza suscripciones@panoramaacuicola.com
Editorial
Noticias de la industria
Economía
Niveles óptimos de harina de pescado y metionina en dietas, para juveniles de Litopenaeus vannamei, para el máximo rendimiento del crecimiento con eficiencia económica.


Alternativas
Efectos de las especies probióticas, aplicadas en el agua de los estanques de cría intensiva y en el tracto intestinal del camarón blanco del Pacífico, Litopenaeus vannamei.
Noticias Ecuador
Directorio
Análisis
OFICINA EN LATINOAMÉRICA
Empresarios No. #135 No. Int. Piso 7 Oficina 723, Col. Puerta de Hierro, C.P. 45116 Zapopan, Jal., México. Cruza con las calles Av. Paseo Royal Country y Blvrd. Puerta de Hierro Tels: +(33) 8000 0578
OFICINA EN ESTADOS UNIDOS DP INTERNATIONAL INC. 401 E Sonterra Blvd. Sté. 375 San Antonio, TX. 78258 info@dpintertnatinonalinc.com
COSTO DE SUSCRIPCIÓN ANUAL $750.00 M.N. DENTRO DE MÉXICO USD $100.00 EE.UU., CENTRO Y SUDAMÉRICA €80 EUROPA Y RESTO DEL MUNDO (SEIS NÚMEROS POR UN AÑO)
PANORAMA ACUÍCOLA MAGAZINE, Año 28, No. 5, julio - agosto 2023, es una publicación bimestral editada y distribuída por Design Publications, S.A. de C.V. Av. Empresarios #135 Piso 07 Oficina 723 Col. Puerta de Hierro CP. 45116. Zapopan, Jalisco, México. Tel: +52 (33) 80 00 05 78, www.panoramaacuicola.com, info@dpinternationalinc.com. Editor
Responsable: Salvador Antonio Meza García. Número de Reserva de Derechos de Uso Exclusivo 04-2019071712292400-01, licitud de Título No. 12732, Licitud de Contenido No. 10304, ambos otorgados por la Comisión Calificadora de Publicaciones y Revistas Ilustradas de la Secretaría de Gobernación. Permiso SEPOMEX No. PP-14-0033. Impresa por Negocios Gráficos Grafinpren S.A. Teléfono: 04-2221362 ext 28 / 0959537917. Av. C.J. Arosemena Km 2.5 Antiguo Coliseo Granasa, Guayaquil, Ecuador. Este número se terminó de imprimir el 31 de julio de 2023 con un tiraje de 3,000 ejemplares.
La información, opinión y análisis contenidos en esta publicación son responsabilidad de los autores y no reflejan necesariamente el criterio de esta editorial. Queda estrictamente prohibida la reproducción total o parcial de los contenidos e imágenes de la publicación sin previa autorización de Design Publications, S.A. de C.V.
Tiraje y distribución certificados por Lloyd International
Visite nuestra página web: www.panoramaacuicola.com
También síganos en:

Artículo de fondo Camino hacia la transformación azul de la industria acuícola en Colombia.
Artículo de fondo El Seguro acuícola: indispensable en la transferencia del riesgo y base fundamental para la seguridad alimentaria.

Artículo Efecto de un limitado suministro de oxígeno disuelto, sobre el uso del alimento y el rendimiento del juvenil Litopenaeus vannamei.
Artículo Efecto de la sustitución de harina de subproductos avícolas por harina de subproductos bovinos en el rendimiento global del Litopenaeus vannamei.



Artículo MegaSphe®
Alimento de tecnología avanzada para larvicultura y precría de camarones.
Artículo
Predicción de posibles biomarcadores microbianos autóctonos en Penaeus vannamei, identificados mediante metaanálisis y modelización metabólica a escala genómica.




Artículo
Capacidad de GPC8TM como potente desinfectante contra Vibrio parahaemolyticus en el cultivo del camarón blanco del Pacífico (Penaeus vannamei).
Artículo
La mejora genética y los bajos preciosde las postlarvas (PL) crean un peligro oculto para los productores de camarones.

Artículo ¿Cómo podemos construir un modelo de acuicultura sustentable?
Artículo
Imenco Aqua Chile: soluciones inteligentes para la industria acuícola.
Artículo
Bio RED®Plus Carotenoides en la nutrición acuícola.
Artículo
Más de 150 EXHIBIDORES confirmados en la Feria Internacional Expo Pesca & Acuiperú 2023.


Inocuidad alimentaria y trazabilidad: lo inevitable en el comercio mundial de los productos de la acuicultura.
¿Qué falta para consolidar la maricultura? (Parte 1)
La guerra de las proteínas.
Carbono azul: ¿Qué es y cuál es su potencial para el financiamiento de la acuicultura?
¿Por qué la “tecnificación” es un arma de doble filo?

Evaluación de la calidad de ingredientes en alimentos balanceados, por microscopia óptica, ante el cambio climático (Parte 2).
Relación carbono-nitrógeno (C:N) en acuicultura simbiótica y su importancia para los cultivos acuícolas.

Se estima que la población mundial alcanzará los 9,000 millones de personas para el año 2050, y que esta expansión acarreará un aumento de las necesidades mundiales de alimentos durante la primera mitad del presente siglo (FAO, 2022). La capacidad de mantener los suministros alimentarios para una población creciente y expectante, dependerá de la posibilidad de maximizar la eficiencia y sostenibilidad de los métodos de producción. Según los pronósticos, los cambios climáticos mundiales afectarán negativamente dichos suministros.
La lectura de gran cantidad de información, publicada a nivel mundial, permite establecer que las modificaciones más notables y significativas, asociadas con el cambio climático, son el aumento gradual de las temperaturas mundiales medias y de las concentraciones de gases de efecto invernadero.
Los debates y controversias versan, sin embargo, sobre el grado de los cambios de los principales componentes, tales como la temperatura mundial, el incremento del nivel del mar y el alcance de los efectos de las precipitaciones que estamos experimentando; sin embargo las repercusiones del cambio climático podrían manifestarse, directa o indirectamente, y no todas se traducirán en consecuencias sobre la acuicultura.
Así como sucede con cualquier práctica de cultivo, las prácticas acuícolas se definen espacial y temporalmente así como por su alcance, y son bastante manejables. Además, la producción por acuicultura se concentra en ciertas regiones climáticas y en ciertos continentes, con un conjunto de prácticas sectoriales bien definidas. Sin embargo, es preciso reconocer que la expansión de la acuicultura en las diferentes regiones puede, de hecho, sufrir modificaciones por causa del cambio climático,
en particular, en las zonas y regiones donde la acuicultura misma puede proporcionar posibilidades de adaptación para otros sectores.
En la actualidad, la contribución de la acuicultura al abastecimiento de productos pesqueros para alimentación queda reflejada en el aporte creciente a las cifras totales relacionadas con la pesca en el producto interno bruto (PIB) de algunos de los principales países productores. Considerando el crecimiento de la población humana y el estancamiento del crecimiento de la pesca de captura, se espera que, para satisfacer la demanda futura, el suministro de alimentos provenientes de la acuicultura debe aumentar.
La acuicultura es una actividad predominante en las regiones climáticas tropicales y subtropicales, y con el propósito de hacer frente y mitigar los impactos del cambio climático en estas regiones, ha sido necesario adoptar, por el momento, un enfoque centrado en el desarrollo de estrategias de adaptación, en especial, si se busca reducir la distancia que separa el suministro de la demanda de pescado mediante la acuicultura. No obstante, no es posible desconocer el potencial de crecimiento de la acuicultura en otras regiones.
Con base en el potencial de desarrollo de la acuicultura y del potencial de efecto del cambio climático, se puede considerar que las pesquerías representan una de las principales fuentes de insumos, al suministrar alimentos y en menor medida semilla, las alteraciones resultantes del cambio climático mundial que se registren en ellas, se harán sentir en los sistemas de acuicultura; de especial relevancia se debe hacer notar que, la designación de las diferentes áreas aptas para el cultivo, se verá afectada tanto en espacio como en su temporalidad; sin embargo también se
verá reflejada en la disponibilidad y los precios de los recursos, como la proteína de pescado que se usa para la fabricación de alimentos.
9 Existe mucha información al respecto; sin embargo, se debe de evaluar las consecuencias del cambio climático sobre la acuicultura, en los siguientes aspectos: 99 Repercusiones por enfermedades, pudiendo influir en la selección de diferentes rasgos del ciclo biológico y afectar la transmisión de los parásitos y, potencialmente, su virulencia.
9 Repercusiones sociales, siendo un punto de especial los cambios en las rutas migratorias y en la biogeografía de las poblaciones y su efecto en el esfuerzo pesquero.
Por lo anterior, y considerando la resiliencia y adaptabilidad, así como la gran variedad de las especies o grupos de especies cultivadas, la acuicultura pueda responder positivamente a las repercusiones climáticas. Para que esto sea posible, debe existir una política adecuada y deben tener lugar cambios socioeconómicos que es preciso respaldar y suplementar con avances técnicos adecuados. De preferencia, debe adoptarse un enfoque holístico y un enfoque que proceda de abajo hacia arriba, y no al contrario. Esto último es crucial, ya que, el grueso de las actividades acuícolas son actividades en pequeña escala; las empresas son propiedad de los acuicultores y son ellos quienes las operan y gestionan, en especial en Asia, región que es el epicentro de la acuicultura mundial. Los cambios adaptativos solo se podrán llevar a cabo eficaz y oportunamente, si se incorporan los conocimientos nativos y se obtiene la cooperación de las bases.
Editor Asociado Marco Linné Unzueta
Skretting acaba de dar a conocer su último informe de sostenibilidad, en el que la empresa líder mundial en la fabricación y suministro de alimentos para la acuicultura muestra un nivel de transparencia sin precedentes, en comparación con años anteriores. El informe proporciona una descripción completa del impacto ambiental de la compañía, revelando específicamente la huella de carbono absoluta de alcance 1, 2 y 3, al tiempo que destaca logros significativos en línea con su hoja de ruta de sostenibilidad. “Estamos encantados de presentar nuestro informe de sustentabilidad más transparente hasta la fecha”, puntualizó la Directora Ejecutiva de Skretting, Therese Log Bergjord: “Reconocemos la necesidad urgente de rendición de cuentas y acción, y este informe muestra nuestro firme compromiso con la transparencia”.
Respaldado por los pilares de sostenibilidad de salud y bienestar, clima y circularidad, y buena ciudadanía, como se define en RoadMap 2025, desde Skretting aseguran que, la compañía, ha demostrado su compromiso inquebrantable con las prácticas sostenibles y las operaciones comerciales responsables. Su último informe de sustentabilidad presenta, ante las partes interesadas, una descripción detallada de los esfuerzos de la compañía en estas áreas, consolidando su posición como pionera en la industria.
El informe, continúa Log Bergjord, “describe el progreso que hemos logrado en el logro de nuestros ambiciosos objetivos de sustentabilidad, al mismo tiempo que realiza llamados a la acción para nosotros mismos, nuestros proveedores, nuestros clientes y nuestros compañeros”.

El informe de sostenibilidad, proporciona un desglose completo de la

El último informe de sostenibilidad de compañía alcanza un nivel de transparencia sin precedentes
Salmones de Chile y Salmones Multi-X son parte del proyecto de investigación “Reducción de lodos de acuicultura a partir de escalamiento de nueva tecnología basada en depuración de RILes”
En el proyecto, el tratamiento de efluentes se realiza a través de un sistema denominado Intelligence Passage (IP). Se trata de una tecnología que, de acuerdo a los primeros desarrollos experimentales –Technology Readiness Level–, tiene una fácil implementación y manejo, así como una alta eficiencia. Además, es inolora, no requiere aplicación de químicos o aditivos adicionales al agua, ni de un operador experto para su manejo.
Desde la UCN destacaron que el proyecto presenta diversos retos, pues no solo se trata de una iniciativa pionera, sino que la investigación de campo se realizará en los meses más fríos del año, donde estos procesos reducen su eficiencia, pues se trata de una tecnología que incluye fases microbiológicas. El interés de los investigadores es evaluar la planta bajo condiciones críticas de cargas y ambientales.
Al respecto Barraza dijo que “diseñar el prototipo semi-industrial de la planta, implementarla y ponerla en operación permitirá evaluar la eficiencia de la tecnología de depuración de efluentes, la reducción de lodos generados en el proceso de depuración, además del impacto en los costos de tratamiento”. Este sistema, agregó, “es amigable con el medioambiente”.
En promedio una piscicultura comercial (1,000 toneladas alimento/año) puede generar entre 200
y 400 g de sólidos por kilogramo de alimento entregado, lo que se traduce en una producción entre 15 y 33 toneladas de lodos (materia seca) al mes, es decir, entre 150 m³ y 330 m³ de lodos hidratados, explicó la Licenciada en Acuicultura, Macarena Morales Godoy.
La disposición final de estos lodos es un problema de alta complejidad y conociendo los buenos resultados de las plantas de tecnología IP en la industria en Japón, y el éxito obtenido en Chile en la depuración de aguas residuales de origen domiciliario en la planta instalada en Río Hurtado, en la Región de Coquimbo, los investigadores de la UCN vieron la oportunidad de utilizarla en el sector acuícola.

La tecnología IP puede ser fácilmente acoplada a un genérico dedicado al cultivo de salmones, lo que permitiría el tratamiento de los RILes removidos por los dispositivos de tratamiento convencionales de sólidos suspendidos del agua de cultivo efluente. Este el principal desafío de la investigación.
A partir de resultados validados a pequeña escala, dijo Barraza, “consideramos que se puede tratar efluentes de aguas provenientes del sistema productivo acuícola y/o residuos de pisciculturas. Por ello, resaltó, se espera contar con un paquete tecnológico cuyo principal componente será una tecnología que reduzca el nivel de generación de los lodos producto de la depuración de los efluentes acuícolas, contribuyendo favorablemente con el medio ambiente”.

La Universidad Católica del Norte pone en marcha dos plantas piloto de depuración de efluentes acuícolas, construidas con una innovadora tecnología japonesa
Investigadores del Centro Oceanográfico de Murcia del Instituto Español de Oceanografía (IEO, CSIC) dieron a conocer que han logrado por la primera vez la reproducción del atún rojo (Thunnus thynnus) mantenido en cautividad en una instalación en tierra. El hito, explicaron, es un logro a nivel mundial y se ha conseguido en su Instalación para el Control de la Reproducción del Atún Rojo (ICRA), la infraestructura creada para el control de la reproducción de esta emblemática especie. Los investigadores responsables de la instalación, son los expertos Aurelio Ortega y Fernando de la Gándara.
El IEO, que ya había conseguido el cierre del ciclo biológico, de la especie en cuestión en el año 2016, en jaulas flotantes en el mar, es un Centro Nacional del Consejo Superior de Investigaciones Científicas (CSIC), dependiente del Ministerio de Ciencia e Innovación, dedicado a la investigación en ciencias del mar, especialmente en lo relacionado con el conocimiento científico de los océanos, la sostenibilidad de los recursos pesqueros y el medio ambiente marino.
Miles de huevos fertilizados en 48 horas
Efectivamente, el Centro Oceanográfico de Murcia del IEO posee, desde el año 2015, una instalación para el control de la reproducción del atún rojo (ICRA), ubicada en el término municipal de Cartagena, dentro de la Comunidad Autónoma. Junto con la Planta de Cultivos de Mazarrón, que se encuentra a un escaso kilómetro de distancia, la instalación fue declarada, en diciembre de 2018, ‘Infraestructura Científico y Técnica Singular para el Cultivo del Atún Rojo’, del Ministerio de Ciencia e Innovación.
La Asociación Empresarial de Acuicultura de España (APROMAR) celebró hace pocos días en Madrid su Asamblea General Ordinaria 2023, en la que además de revisar cuestiones estatutarias entregó la distinción Acuicultor de Oro 2023. En esta oportunidad, el galardón fue para Pedro

El Instituto Español de Oceanografía consigue, por primera vez a nivel mundial, la reproducción del atún rojo en instalaciones en tierra
APROMAR distingue como Acuicultor de Oro a Pedro Ramos, poseedor de una larga carrera profesional que finalizó como Director General de
españoles y mundiales, especialmente del salmón de acuicultura, así como la importancia de la perseverancia en las acciones de comunicación.


La jornada se completó con cuestiones estatutarias de la asociación APROMAR, incluida la renovación de siete puestos de su Junta Directiva y el repaso por las principales actividades que la asociación tiene en curso, así como la negociación laboral colectiva con los sindicatos, las actividades en proyectos de innovación, la comunicación a la sociedad y la promoción de la marca colectiva Crianza Mares y Ríos de España.
A su vez, los asociados aprobaron sumar a la lista de empresas adheridas a APROMAR a las compañías Piscifactorías Andaluzas, Piscifactorías Santa Ana, Piscilor y Mundova, con las que se ve reforzada la ya muy alta representatividad de la entidad en la acuicultura española.
Recordemos que la Asociación Empresarial de Acuicultura de España es una organización de carácter profesional, voluntaria y de ámbito nacional que representa una producción que supera las 65,000 toneladas de productos acuáticos de crianza, según datos de 2022; donde prácticamente la totalidad de productores de peces de crianza (dorada, trucha, rodaballo, lubina, anguila, lenguado, esturión y corvina), moluscos (almejas, abalones y ostras), microalgas y crustáceos (langostinos) de España están adheridos a APROMAR.
La entidad empresarial está también reconocida desde 1986 como Organización de Productores (OPP30) a efectos nacionales y de la Unión Europea, es miembro de la Federación Española de Industrias de la Alimentación y Bebidas (FIAB) y participa en la Federación Europea de Productores de Acuicultura (FEAP).

El bienestar de un organismo es inseparable del grado de sufrimiento y de los estados positivos que experimenta en un momento determinado. Este artículo presenta protocolos específicamente diseñados para evaluar el bienestar del camarón blanco del Pacífico Penaeus vannamei, en todas las fases de su ciclo de producción, desde la reproducción, pasando por la cría de larvas y el transporte de postlarvas, hasta la cría de juveniles en estanques de tierra.
La cadena de producción del camarón de cultivo se considera uno de los sistemas agroalimentarios de producción de proteína animal más controvertidos del mundo. Actualmente, la evolución de las prácticas de cría del camarón se está gestando en varios frentes: intensificación de los sistemas de producción, certificaciones y regulaciones, mejora genética de los organismos, mejora de la alimentación y nutrición, controles higiénico-sanitarios y bioseguridad en las granjas de camarón, solo por nombrar algunos.

Este escenario de cambio, basado en el desarrollo científico y tecnológico del sector, ayuda a entender como la producción mundial del camarón blanco del Pacífico, Penaeus vannamei, ha aumentado, casi un 53%, en 5 años. Sin embargo, es propio de la naturaleza humana que, a pesar de todos estos avances, exista a menudo la tentación de aferrarse a métodos y conceptos de producción tradicionales.
El bienestar de un organismo es inseparable del grado de sufrimiento y de los estados positivos que experimenta en un momento determinado. La sensibilidad se refiere a la capacidad de un animal de percibir conscientemente lo que


refiere a niveles de referencia que afectan el estado fisiológico, salud y comportamiento de los organismos en un grado inaceptable, por lo que su bienestar y supervivencia están comprometidos.
La fase reproductiva abarca desde la selección de los organismos para la formación de bancos de cría hasta su cuidado (en tanques o estanques de tierra), pasando por el apareamiento y el desove. Se seleccionaron 11 indicadores ambientales para evaluar el bienestar de los reproductores criados en granjas de camarones. Además de los parámetros empleados habitualmente para determinar la calidad del agua en una granja (temperatura, pH, alcalinidad, amonio, nitrito y salinidad), se tomaron en cuenta el fotoperiodo (cuando esta variable está controlada), la ausencia de depredadores (terrestres o acuáticos) y la densidad de población. La presencia controlada de depredadores terrestres significa que están físicamente presentes en el medio, pero no tienen acceso directo a los camarones. Así ocurre, por ejemplo, cuando las vallas protectoras impiden que las aves accedan a los estanques. Sin embargo, en estos casos, incluso el contacto indirecto con el depredador podría ser perjudicial para el bienestar del camarón.
Los indicadores sanitarios de los reproductores de P. vannamei pueden medirse principalmente mediante la observación directa de las características anatómicas de los organismos. La luminiscencia, cuando se observa en organismos en ambientes oscuros, ya sea en instalaciones de cría o en el laboratorio, es indicativa de la presencia de bacterias del género Vibrio. La madurez sexual se refiere a las características de los camarones seleccionados para la reproducción y el desove en el laboratorio. Los procedimientos invasivos se consideran el punto más crítico para el bienestar de los camarones en esta fase del proceso de producción y deben evitarse. Las tasas de mortalidad se evalúan de forma acumulativa (desde el inicio de esta fase hasta el momento del análisis o al final del proceso reproductivo).
Por selección genética se entiende la aplicación (o no) de protocolos, debidamente normalizados, utilizados por el laboratorio en la selección y cría de organismos de granja. Los indicadores nutricionales de los reproductores de P. vannamei incluyen, además de un indicador directo (llenado del tracto digestivo con alimento), algunos aspectos esenciales de la rutina de alimentación, como composición y tipo de alimento ofrecido, propor-
ción de proteína bruta en la dieta artificial de los reproductores, cantidad suministrada (como porcentaje de la biomasa de camarones) y frecuencia de alimentación. Los indicadores de comportamiento se refieren a la forma como nadan los camarones, el comportamiento alimentario durante el manejo y los resultados relacionados con el uso de métodos de aturdimiento cuando se realizan procedimientos invasivos en los organismos.


los camarones durante el proceso de producción, a saber: camarones de menos de 0.9 g, juveniles de 1.0 a 3.9 g, y en dos tamaño en los que se pueden comercializar para el consumo, de 4.0 a 8.9 g y de 9.0 a 15.0 g. Los otros tres indicadores son independientes del tamaño de los organismos. Se consideraron dos escenarios para la distribución del alimento: a) distribución del alimento sobre la superficie del estanque y b) uso de bandejas de alimentación. Los indicadores de comportamiento son específicos de las distintas fases del proceso de producción en una granja de camarones. Cuanto más inquietos están, más saltan (comportamiento de huida) y más se estresan.

Las variables ecológicas y biológicas son tan dinámicas e interactivas que es imposible pensar en técnicas de gestión estandarizadas, o controlar las variables ambientales en los estanques y criaderos de camarones. En cambio, es perfectamente posible, establecer rangos aceptables de variación de los parámetros ambientales, asegurar el suministro de alimento natural a los organismos, ofrecer pre y probióticos como parte de la dieta de los camarones, estimular el crecimiento de comunidades microbianas benéficas, realizar pruebas periódicas sobre el estado de salud de los camarones de cría y promover su aturdimiento antes del sacrificio. Los protocolos presentados pretenden ayudar a medir el impacto de todas estas prácticas en el bienestar de los P. vannamei cultivados.

Conclusiones
Este trabajo representa la primera propuesta de indicadores que abarquen todas las fases del proceso de producción de una especie de camarón y, en este caso, de una especie de camarón esencial para la acuicultura mundial. Sin embargo, es previsible que a partir de ahora converjan, cada vez más, las tecnologías de control del bienestar del camarón cultivado y las dirigidas específicamente a las Buenas Prácticas Acuícolas. Esta evolución se producirá a través de la denominada “acuicultura de precisión” (Samocha et al., 2002), que incluirá tecnologías como uso de biosensores, registradores de datos y sistemas de alerta temprana (Albalat et al., 2022); monitoreo de organismos

La industria de alimentos, para camarones, busca constantemente oportunidades para minimizar la dependencia de la costosa harina de pescado y mantener su rentabilidad y sostenibilidad. Sin embargo, se dispone de muy poca información sobre los niveles óptimos de metionina en la dieta, en relación con los distintos niveles de harina de pescado, con el fin de alcanzar el máximo rendimiento del crecimiento del camarón blanco del Pacífico (Litopenaeusvannamei) con eficiencia económica.
Por: Redacción de PAM*Los alimentos compuestos industriales para camarones figuran entre los mayores consumidores mundiales de harina de pescado dentro de la industria acuícola. En consecuencia, su sustitución por otras proteínas ha sido objeto de múltiples investigaciones. La mayoría de los estudios han demostrado que, los niveles de harina de pescado en la dieta, pueden reducirse significativamente sin provocar efectos adversos en el crecimiento de los camarones.

Las proteínas más utilizadas, para sustituir la harina de pescado, en los alimentos para camarones son los derivados de subproductos de origen animal y de la agricultura. Independientemente de las fuentes de proteínas elegidas, los estudios han comprobado que la formulación de dietas bajas en harina de pescado depende de una suplementación equilibrada de aminoácidos esenciales, ácidos grasos y atrayentes del alimento.
La metionina (Met) se considera el aminoácido esencial (EAA, por sus siglas en inglés) más afectado cuando se cuestiona la harina de pescado. Los niveles recomendados de Met en los alimentos para camarones oscilan entre el 0.7% y el 1.0% de la dieta, dependiendo de diversos factores como la especie de camarón, la fuente de Met suplementario, la fase de crecimiento, las condiciones de cultivo y el nivel de proteína en la dieta. Sin embargo, se dispone de muy poca información sobre los niveles óptimos de Met, en
la dieta en relación con los distintos niveles de harina de pescado (FML, por sus siglas en inglés), con el fin de alcanzar el máximo rendimiento del crecimiento del camarón con eficiencia económica.
En el presente trabajo se evaluó el crecimiento de los juveniles de Litopenaeus vannamei, en condiciones de cultivo intensivo, la digestibilidad del alimento y el ahorro por reducción de harina de pescado, con la suplementación dietética de DL-metionil-DL-metionina.
El estudio se realizó en dos etapas experimentales. La primera se diseñó para evaluar el rendimiento del crecimiento de camarones alimentados con diferentes niveles de FM y Met. En la segunda, se determinaron los coeficientes de digestibilidad aparente (ADC, por sus siglas en inglés) de la proteína bruta (ACPDC) y los aminoácidos (AAADC) de dietas con distintos
niveles de FM, incluyendo un contenido fijo de Met en la dieta. Para la evaluación del crecimiento se utilizó un sistema de cría al aire libre. La especie de camarón estudiada fue el camarón blanco del Pacífico L. vannamei, adquirido como postlarva (PL) de un criadero comercial. Se empleó como referencia un alimento comercial para camarones de cultivo, con 39.25% de proteína cruda y 6.90% de lípidos totales (dieta control, CTL). Para el análisis económico se calculó primero el costo de formulación de cada dieta individual, utilizando los precios del mercado local de cada ingrediente y aditivo del alimento.
En los tanques exteriores, la supervivencia de los camarones fue alta (92.7% ± 4.7%) y no resultó afectada por el contenido de Met en la dieta, el nivel de inclusión de FML o su interacción (p > 0.05) (Tabla 1).
Niveles óptimos de harina de pescado y metionina en dietas, para juveniles de Litopenaeusvannamei , para el máximo rendimiento del crecimiento con eficiencia económica

(NEAA, por sus siglas). En tanques interiores los camarones, alimentados con una dieta sin FML, alcanzaron la supervivencia más alta en comparación con otros tratamientos dietéticos. La supervivencia alcanzó una media del 87.5% ± 7.8% (p > 0.05). Al momento de la cosecha, los camarones alimentados con 0% FML crecieron a 0.62 ± 0.04 g/semana y alcanzaron 12.69 ± 0.55 g de PC, ambos significativamente inferiores a los de otros tratamientos dietéticos (p < 0.05). Sin embargo, no se detectaron diferencias estadísticamente significativas en el crecimiento del camarón (557 ± 80 g/m2), ni en el FCR (2.68 ± 0.37). Hubo un AFI significativamente menor cuando los camarones fueron alimentados con 0% y 6% de FML, pero este último no difirió estadísticamente del 12% y 18% de FML (p > 0.05).
El costo total de producción del camarón, los ingresos brutos, los beneficios y el rendimiento de la inversión dependieron del FCR, el rendimiento, el PC del camarón y los costos de formulación, es decir, el precio de venta del alimento. Los costos de formulación oscilaron entre un mínimo de 0.706 USD/kg (0% de FML con 0.56% de Met) y un máximo de 0.943 USD/kg (18% de FML con 0.82% de Met). Tanto la inclusión de FML en la dieta como el contenido total de Met afectaron a los costos de la fórmula.
Una reducción en FML de 18% a 12%, 6%, y 0% a 0.69% de Met die-
tético resultó en ahorros de fórmula de 6.2%, 13.3% y 23.1%, respectivamente. El aumento del contenido de Met, en la dieta con el mismo nivel de FML, también elevó los costos de la fórmula. Sin embargo, el aumento fue menos crítico. El aumento del contenido total de Met de 0.58% a 0.69% y 0.82% en las dietas sin FML, influyó en los costos de la fórmula en un 0.7% y un 1.5%, en cada caso. Se observó un aumento similar del costo de la fórmula con un 18% de FML.
La cría de camarones con una dieta que contenía un 18% de FML produjo el retorno sobre la inversión (ROI, por sus siglas en inglés) más bajo, con un 14.3% ± 6.4%. Destaca el hecho de que el ROI
más alto se obtuvo con dietas que no contenían FML (33.2% ± 8.4%) o que contenían solo un 6% (26.5% ± 7.9%). Sin FML, el ROI fue significativamente mayor que con FML al 12% y al 18%. A niveles moderados de inclusión en la dieta, es decir, 6% y 12% de FML, no se observaron diferencias en el ROI.


Este estudio ha demostrado que los niveles de FML y Met (Met + Cys) en la dieta, y su interacción, influyen significativamente en el PC del camarón. Las respuestas en el PC en función del nivel de FML variaron según el contenido dietético de Met. Con el contenido más bajo de Met en la dieta, es decir, 0.58%, se obser-
vó que la FML solo podía reducirse del 18% al 12%. Mayores reduccio nes condujeron a una reducción del PC del camarón al momento de la cosecha. A niveles moderados de Met en la dieta, es decir, 0.69%, la FML pudo eliminarse completa mente sin ningún impacto en el PC del camarón, pero con un efecto adverso en el rendimiento. En com paración con el nivel más alto de Met en la dieta, es decir, 0.82%, la FML pudo reducirse de 18% a 6%, pero la eliminación completa afectó negativamente al PC. Por lo tanto, los niveles de Met requeridos para maximizar el PC del camarón a 0% y 6% de FML oscilaron entre 0.69% y 0.82%, mientras que a 12% y 18%, solo se necesitó 0.58%. En condicio nes de tanque exterior e interior, el nivel óptimo de FML en la dieta se alcanzó al 6%, sin un efecto adverso sobre el rendimiento del crecimien to de L. vannamei
Desde el punto de vista econó mico, la eliminación de FML fue tan competitiva como la inclusión de 6% de FML, siendo ambas más ventajosas que 12% y 18% de FML. Los costos de producción de las

más conducen a un aumento de los costes, que no son compensados por mayores ingresos. En conclusión, la cantidad total de Met en la dieta necesaria para maximizar el rendimiento del crecimiento del camarón depende de la cantidad de FML en la dieta. Mayores cantidades de DL-metionil-DL-metionina reducen la dependencia de la FML. Una suplementación dietética total de DL-Met-Met del 0.34% puede reducir la inclusión de FML del 18 al 6%, sin ningún efecto negativo en el
La versión original,
 JUVENILE LITOPENAEUS VANNAMEI TO SUPPORT
JUVENILE LITOPENAEUS VANNAMEI TO SUPPORT
Los probióticos se han aplicado habitualmente en las granjas comerciales de camarones para aumentar la producción de los estanques, basados en resultados de estudios in vitro o ensayos in vivo en laboratorio. Este artículo resume los aspectos más relevantes de una investigación, cuyo objetivo fue analizar la composición y abundancia de especies probióticas comerciales aplicadas en el agua de un sistema de acuicultura intensiva para la cría de Litopenaeusvannamei.
Por: Redacción de PAM*Los probióticos se han considerado un enfoque ecológico para aumentar el rendimiento de la producción acuícola a través de distintos mecanismos, como el mantenimiento de la calidad del agua, el rendimiento del crecimiento o la tasa de supervivencia de los organismos acuáticos. Estudios han confirmado que la aplicación de probióticos ha permitido reducir significativamente el

uso de antibióticos en la industria acuícola y evitar la aparición de genes de resistencia a los antibióticos en los microbios. Se ha documentado, que algunos probióticos, producen enzimas digestivas como proteasa, amilasa, lipasa, alginato liasa y celulasa, que ayudan a los huéspedes a digerir las dietas ingeridas. Asimismo, las cepas probióticas producen compuestos antimicrobianos activos contra patógenos bacte-
rianos, y algunas especies tienen la capacidad de degradar y prevenir la acumulación de residuos acuícolas en los estanques de cultivo, incluidos los residuos orgánicos sólidos o las sustancias químicas tóxicas solubles, como el amoníaco (NH3) o el nitrito (NO2). La mayoría de estos estudios se basaban en estudios in vitro o ensayos de laboratorio in vivo en sistemas de cría a muy pequeña
Efectos de las especies probióticas, aplicadas en el agua de los estanques de cría intensiva y en el tracto intestinal del camarón blanco del Pacífico, Litopenaeusvannamei

Estos resultados indicaron que las Pseudomonas putida procedentes de probióticos comerciales tuvieron dificultades para adaptarse y proliferar en el agua de cría de los estanques de camarones. Según los resultados de la NGS, la especie más abundante fue P. psychrotolerans (213 secuencias), seguida de P. azotoformans (81 secuencias) y Pseudomonas sp (9 secuencias).
Perfildelascepasprobióticas en los tractos intestinales
De los intestinos de camarones recolectados en el estanque 1, un total de 172 secuencias bacterianas
(0.2% del total de bacterias identificadas) se asignaron al orden
Lactobacillales. De estas, 90 secuencias (52% de Lactobacillales) pertenecían al género Streptococcus, 33 secuencias (19% de Lactobacillales) al género Enterococcus, 17 secuencias (10% de Lactobacillales) al género Lactobacillus , 9% (16 OTU) al género Weisella, 5% (9 secuencias) al género Lactococcus, y 4% (7 secuencias) al género Leuconostoc. Las 17 secuencias del género Lactobacillus se identificaron como tres especies: L. ruminis (12 secuencias), L. aviaries (4 secuencias) y Lactobacillus sp (1 secuencia) (Tabla 2).
De la muestra tomada en el estanque 2, un total de 1,669 secuencias bacterianas (2% del total de bacterias identificadas) se asignaron al orden Lactobacillales; 1,569 secuencias (94.0% de Lactobacillales) pertenecían al género Lactobacillus, 84 secuencias (5.0% de Lactobacillales) a Streptococcus, 11 secuencias (0.7% de Lactobacillales) a Enterococcus y una secuencia a Weisella. Se identificaron 12 especies a partir de las 1,569 Lactobacillus, siendo las tres más abundantes Lactobacillus sp (469 secuencias), L. pentosus (339 secuencias) y L. reuteri (287 secuencias). Mientras que, las especies con menor abundancia fueron L. agilis y L. acidipiscis, con una única secuencia cada una.
En el estanque 3, un total de 1,265 secuencias bacterianas provenientes de los intestinos de los camarones se asignaron al orden Lactobacillales. De estas secuencias, 945 (75% de Lactobacillales) se identificaron como pertenecientes al género Lactobacillus. La anotación taxonómica inferior indicó que las secuencias se clasificaban
en 12 especies bacterianas, siendo las más abundantes Lactobacillus sp (216 secuencias), L. pentosus (209 secuencias) y L. reuteri (101 secuencias).


De los intestinos de los camarones tomados en el estanque 1, 48 secuencias (0.05% del total de bacterias identificadas) se clasificaron como Bacillaceae: 18 se identificaron como Bacillus badius, 24 Bacillus sp y 6 B. thermoamylovorans (Figura 1). De las muestras del estanque
2, se identificaron 43 secuencias (0.05% del total de bacterias identificadas), las cuales se asignaron a Bacillaceae (Figura 1). De ellas, 36 secuencias (84% de Bacillaceae) pertenecían al género Oceano bacillus, seis (14% de Bacillaceae) al género Bacillus, y se identificaron como cuatro especies, a saber: B. thermoamylovorans (2 secuencias), B. badius (2 secuencias), B. coagulans (1 secuencia) y Bacillus sp (1 secuencia).


desarrolló en el agua de cría era diferente del Bacillus comercial. Estos resultados sugieren que los probióticos introducidos fueron incapaces de adaptarse a sus nuevos entornos y no consiguieron proliferar y crecer en los lugares de destino (tracto intestinal de los camarones blancos o agua de cría). Según estudios anteriores, existe la posibilidad de que las bacterias comerciales no sobrevivieran. Las especies probióticas se aislaron en condiciones ambientales muy diferentes y, por tanto, tuvieron dificultades para adaptarse a las de los estanques o de los intestinos de los camarones. Con frecuencia se ha atribuido una gran pérdida de viabilidad a las elevadas concentraciones de ácido y sales biliares en el estómago y los intestinos. La diferencia entre las condiciones del agua de cría y las de cultivo, incluidos oxígeno disuelto, pH, salinidad, temperatura y fuentes de nutrientes, afectarán la tasa de crecimiento de las bac-

terias probióticas y el rendimiento celular total. Otra posibilidad es que las bacterias nativas compitan con las probióticas introducidas por el mismo sustrato orgánico, como el carbono. Este estudio podría explicar la inconsistencia de los resultados relativos a la eficacia de los tratamientos probióticos sobre la supervivencia y el crecimiento de los camarones blancos.
Según Chauhan y Singh (2019), la viabilidad de los probióticos es un factor muy importante en las especies acuícolas y sirve como uno de los requisitos previos en su selección para la acuicultura. Los probióticos menos viables pueden no contribuir porque los probióticos comerciales no son viables en los sitios de destino; por lo tanto, pueden no contribuir con las granjas de camarones. Esta podría ser la razón por la cual los estudios informan que la aplicación de probióticos no tiene un efecto significativo en los rendimientos de la producción.
Un estudio realizado por HuertaRábago et al. (2019) informó que la adición de probióticos comerciales no afectó a las bacterias dominantes tanto a nivel de phyla como de género en los estanques de cría.
Todos estos hechos sugieren que, los métodos y estrategias para aplicar probióticos a las especies acuícolas, aún deben ser cuidadosamente investigados para aumentar su eficacia.
Entonces, ¿cuál es el efecto de los probióticos en el presente estudio sobre la composición microbiana en general? Los resultados mostraron que la suplementación con probióticos no parece cambiar la estructura de la composición microbiana en el tracto intestinal de los camarones, como lo indica la ausencia de diferencias significativas en los tres principales filos bacterianos analizados (Proteobacteria, Bacteroidetes y Planctomycetes), tanto en el tratamiento probiótico como en los controles.


Colombia se encuentra entre los principales productores acuícolas de América Latina y el Caribe (ALC), por lo que es válido preguntarse:
¿qué oportunidades tiene la industria en Colombia y ALC para continuar su expansión? y ¿qué estrategias podría acoger para garantizar la sostenibilidad de sus operaciones?
La acuicultura es una de las formas más eficientes de obtención de proteína animal de alta calidad, con alto impacto social y económico para América Latina y el Caribe (ALC). Cuenta con una tendencia de incremento acumulado anual de alrededor del 18%, pasando de 17.3 millones de toneladas en la década de 1990-2000 a 104.0 millones de toneladas entre 20152020. En 2020, ALC contribuyó con un 15.7% de la producción global y generó 58.5 millones de empleos (FAO, 2020 y 2022). Además, el consumo promedio de productos acuícolas per cápita en la región es 10.5 kg/año (Souto Cavalli, Blanco Marques, Watterson, & Ferretto da Rocha, 2021), mientras que, el promedio mundial es de 20.5 kg/ año, según el reporte del Foro Económico Mundial, indicando una oportunidad de crecimiento.
En ALC, los principales productores son Chile y Brasil, seguido por Ecuador, México, Perú y Colombia, este último con un incremento en la producción anual, de la última década, desde 338 a 783 millones de toneladas, cuyo desarrollo está siendo direccionado por el cultivo de tilapia del Nilo (Oreochromis
niloticus) , la cual se exporta a Estados Unidos y Europa (Gyalog, Tovar, & Békefi, 2022; Souto Cavalli et al., 2021).
La industria piscícola en Colombia tuvo un comportamiento similar al global, con un incremento del 22.1% en el PIB para el 2020, en comparación con el año anterior (del Castillo, 2022). En general, se espera su fortalecimiento, ya que, ofrece fuentes alternativas de alimento, con bondades nutricionales destacables, a una sociedad
cuyas necesidades alimentarias difícilmente podrían satisfacerse con los productos pesqueros, dada la limitación de los inventarios de peces marinos y continentales (Marrero et al., 2022). Tilapia y trucha son los productos acuícolas de mayor exportación en Colombia, por un valor de US$ 110,130,000 y un peso neto de 18,985 toneladas en 2022 (Fedeacua, 2023).
Frente a estos resultados, es válido preguntarse: ¿qué oportunidades tiene la industria en


de prácticas sostenibles en la acuicultura, así como en la prevención y control de enfermedades animales que puedan afectar a la salud humana. No obstante, las estadísticas del uso de antibióticos en la industria, así como la evaluación de la presencia y prevalencia de genes de resistencia a antibióticos en bacterias, asociadas a los cultivos y ecosistemas próximos, son temas de investigación que merecen atención, debido a que no se cuenta con datos epidemiológicos suficientes (Colombia - Wisconsin One Health, 2018).

Adicionalmente, la conectividad entre los cuerpos de agua es innegable, al igual que el riesgo de contaminación de fuentes naturales, las cuales deben ser preservadas para su uso. Una de las tecnologías más importantes, para la sostenibilidad de la acuicultura, es la implementación de sistemas de reúso de agua, como el RAS (Recirculating Aquaculture Systems) , debido a que son sistemas cerrados que reciclan el agua de cultivo, minimizando la contaminación del medio ambiente (Figura 2).
Los sistemas RAS también tienen la ventaja de permitir el control preciso de las condiciones de producción, lo que resulta en un ambiente más saludable para los peces y mejora la eficiencia del cultivo. Los probióticos pueden ser especialmente útiles en combinación con los sistemas RAS, ya que el ambiente controlado proporciona un entorno óptimo para la proliferación de microorganismos beneficiosos y, de esta manera, evitar el uso de antibióticos (Shi et al., 2022).
Otro aspecto fundamental, en la sostenibilidad de la industria acuícola, es el uso de los alimentos balanceados funcionales. El alimento es una de las inversiones más altas de los ciclos productivos. Los alimentos han recibido atención, desde la perspectiva ambiental, porque incluyen harina de otros pescados, lo cual representa una paradoja en la nutrición, usar peces para alimentar peces y no a la humanidad (Kari et al., 2023).

En Colombia, se requiere incentivar la política de datos abiertos, visibilizando la información con calidad, en tiempo real, unificada y confiable.

Las empresas dedicadas al cultivo de organismos acuáticos no están libres de riesgos que pueden afectar la producción. Aun con todo el esfuerzo de los productores, estos se ven afectados en sus intereses económicos a consecuencia de factores ambientales que, en ciertas ocasiones, pueden provocar situaciones de riesgo.
Por: Biól. Carlos Quiroga Treviño.*La pesca y la acuicultura son asuntos de seguridad nacional, así como parte esencial del quehacer económico y social del país. La acuicultura es el sector, productor de alimentos, que registra el más rápido crecimiento y es fundamental para la seguridad alimentaria de México. La producción acuícola internacional aumentó 50.2% en el periodo comprendido del 2011 al 2020 y en este país el incremento alcanzó un máximo de 53.9% en 2017 (FAO, 2020). Adicionalmente, en los últimos años se registró un incremento en el consumo per cápita anual de 8.91 a 12.00 kilos.
Dadas las previsiones de crecimiento demográfico, se estima que la acuicultura producirá 85 millones de toneladas de alimentos en 2030 (FAO, 2006). Esto significa que el pescado para consumo humano directo, procedente de las piscifactorías, superará en 2030 al volumen capturado por las flotas pesqueras. Es evidente que la acuicultura desempeña un importante papel a la hora de cerrar la brecha entre las producciones pesqueras sostenibles y la creciente demanda de alimentos, provenientes de aguas dulces o marinas.
El perfil geográfico de México genera una gran diversidad de condiciones climáticas y ecosistemas que contribuye al desarrollo de un sector acuícola muy diversificado. El ulterior desarrollo de la acuicultura,
en el país, dependerá de la aplicación exitosa de tecnologías eficientes y de procesos de innovación, modernización y reconversión productiva.
Los efectos del cambio climático, inducido por actividades antropogénicas, representan la principal fuente
de amenazas para la actividad acuícola, que podrían manifestarse en incrementos en la frecuencia o intensidad de huracanes, ondas cálidas o frías, y de fenómenos meteorológicos más complejos, como El Niño –Oscilación del Sur– y su fase fría La






El evento Aqua Expo El Oro 2023 fue inaugurado esta semana en el Hotel Oro Verde de Machala, en Ecuador, con la presencia de autoridades provinciales y de Gobierno además de, por supuesto, todos los miembros del sector aglutinados por la Cámara Nacional de Acuacultura (CNA), organizadora del encuentro. Una vez más, Aqua Expo fue convocado con el objetivo de intercambiar conocimientos y mostrar lo mejor de la industria camaronera, esta vez ante más de 2,000 profesionales de todo el mundo.
En su discurso inaugural, José Antonio Camposano, presidente ejecutivo de la entidad que organiza el evento desde hace más de dos décadas, señaló que “la Cámara ha sido siempre la voz representativa de nuestra industria. Su papel fundamental es ser el referente técnico que vela por el desarrollo competitivo de toda la cadena de valor del mejor camarón del mundo”.
Este año, la exposición sectorial estuvo conformado por una feria comercial con más de 100 stands y un congreso científico-técnico. En el recinto ferial ubicado en Oro Verde participaron 73 empresas ecuatorianas y extranjeras, mostrando lo más destacado de su cartera de productos y servicios.
En tanto, al congreso fueron convocados 18 conferencistas internacionales y ecuatorianos que abordaron los temas de mayor interés e importancia para el sector camaronero en áreas como salud animal, nutrición, producción, manejo, tecnología, mercado, ambiente y prevención de riesgos.
Además de Camposano, la mesa inaugural contó con la presencia de Karina Torres, Viceprefecta de la provincia de El Oro; Jenny Machuca, Vicealcaldesa de Machala; Axel Avedani, Subsecretario de Acuacultura del Ministerio de Producción y Comercio Exterior ecuatoriano; Luis Mejía, Director de Habilitación y Certificación Sanitaria de la Secretaría de Calidad e Inocuidad (SCI); y Marcelo Vélez, Presidente del directorio de la CNA.
En su turno de palabra, el Subsecretario Vedani aseguró que “el éxito de la producción acuícola no la darán las normativas ni impedimentos legales sobre el sector productivo en alguna de sus fases sino la mejora productiva y la eficiencia en sus procesos. De ahí la importancia de eventos como este, en los que la temática siempre se adecúa a la realidad que está atravesando el sector”.
Por su parte, el Presidente del directorio de la CNA Vélez tuvo palabras para los impulsores de la acuicultura en Ecuador. “No quería perder la ocasión para rendir un homenaje de admiración y respeto a los pioneros de nuestro sector y a todos los que tomaron la posta después y que con su trabajo esforzado, han logrado que el sector acuicultor se haya convertido en un pilar de la economía ecuatoriana, generadora de empleo y divisas para el país”, dijo.
Según los organizadores de Aqua Expo, el éxito del evento se evidencia en el crecimiento sostenible e integrador del evento, tanto en número de participantes a la feria comercial como de los asistentes al congreso.
La próxima convocatoria de Aqua Expo será entre los días 23 y 26 de octubre en el Centro de Convenciones de Guayaquil.

Aqua Expo es el evento técnico comercial camaronero más importante del continente americano y se realiza desde hace más de 20 años en Ecuador gracias a la organiza-
ción de la CNA. Su objetivo, dicen desde la organización sectorial, es promover el conocimiento y la innovación de la comunidad acuícola a escala mundial.
El sector camaronero ecuatoriano viajará a Shanghai y Singapur
Por otra parte, y de forma paralela a la realización de Aqua Expo
El Oro, representantes de empresas exportadoras miembros de la CNA participaron en las reuniones convocadas para coordinar su presencia en las importantes ferias de Shanghai y Singapur, en Asia, que se realizarán en los próximos meses de agosto y septiembre.
A través del departamento de Ferias Internacionales, la Cámara Nacional de Acuacultura es la entidad que coordina la presencia de Ecuador en estos importantes encuentros empresariales a nivel internacional.

La compañía líder internacional Skretting acaba de lanzar Elevia, un nuevo e innovador alimento, diseñado para ofrecer una nutrición y una calidad de agua superior en laboratorios de larvas. De acuerdo con la empresa con base en Stavanger, Noruega, y sus investigaciones, la microdieta estable y producida con precisión mejora el rendimiento larvario a la vez que simplifica la gestión de la alimentación y garantiza un sistema de cultivo limpio.
“Elevia reduce los ciclos de producción en los laboratorios y da la reserva energética necesaria para mejorar la fortaleza para el transporte a la finca y la aclimatación”, explicó Marita Monserrate, gerente técnico de Skretting Ecuador “Además, asegura un mejor desempeño en las precrías, reduciendo el costo de los PLs y promoviendo una mayor supervivencia y crecimiento a lo largo de todo el ciclo productivo”, agregó.

La incorporación de nuevas materias primas sostenibles, como los ácidos grasos esenciales omega3 de cadena larga, DHA derivado de algas y proteínas marinas hidrolizadas, permite que las larvas se conviertan en una post-larva fuerte y saludable con una mayor capacidad de resistir y desarrollarse en las precrías de camarones.
Según explican desde Skretting, formulada para facilitar la alimentación natural de las larvas de camarón, Elevia es una solución de nueva generación que supera los métodos
convencionales de alimentación y los ingredientes tradicionales de alimentos acuícolas, estableciendo un nuevo estándar para el rendimiento de los laboratorios.
la lixiviación de lípidos en el sistema de producción, lo que garantiza una calidad del agua más limpia.
Sobrellevar el
Elevia ha conseguido mejorar la capacidad de las larvas para manejar cualquier desafío, al proporcionarles nutrientes que mejoran su sistema inmunológico y su resistencia en general. Esto permite que las larvas sobrelleven el estrés de manera más efectiva causado por los cambios ambientales. Como resultado, la producción de camarón se vuelve más confiable y exitosa, reduciendo los riesgos asociados con las variaciones en las condiciones del agua y de otros factores.
A través de la formulación avanzada, es decir las propiedades físicas de Elevia, la necesidad del uso de múltiples dietas y formación de grumos se reduce significativamente, lo que resulta en operaciones y manejo de alimentación simplificados.
Otra característica clave que contribuye a optimizar las operaciones es la capacidad de la dieta para mantener la estabilidad del agua. Gracias a su composición y encapsulación únicas de ácidos grasos omega-3, se evita
En consecuencia, las partículas de alimentación intactas permanecen estables durante períodos prolongados, lo que minimiza la necesidad de recambios frecuentes. Esto no solo promueve las condiciones óptimas del agua, sino que también facilita el mantenimiento esencial del sistema, al mismo tiempo que alivia la tensión en los filtros biológicos y mecánicos.
Introducción de Elevia en los laboratorios de larvas de camarón
Elevia se produce en las instalaciones LifeStart de última generación de Skretting en Francia, y ya está disponible en Ecuador, al que se le sumarán los mercados de otros países.
“Estamos muy entusiasmados con la introducción de Elevia en los laboratorios de larvas de camarón, particularmente en Ecuador como nuestro país de lanzamiento. Luego de un extenso período de desarrollo que abarcó el brote de COVID y a lo largo de validaciones exhaustivas de los clientes, estamos seguros de que, una vez más, Skretting está aplanando el camino para una nueva generación de producción de larvas de camarón y facilitando así una mejor calidad de PL”, dijo en ese sentido Eamonn O’Brien, gerente de Producto Global LifeStart en Skretting
El recién lanzado producto permite operaciones limpias y simplificadas, así como un mejor rendimiento


Las caídas de oxígeno son evitadas, por los camaroneros, debido a la incidencia directa sobre el consumo del alimento que, en tiempo prolongado, disminuye el crecimiento del camarón e incrementa el factor de conversión alimenticia si no se considera este parámetro al momento de alimentar. De allí, la importancia de investigar acerca del efecto de la composición nutricional como factor influyente en la fisiología del camarón.

El cultivo de camarón es una importante actividad económica a nivel mundial (FAO, 2022), y en el Ecuador proporciona fuentes de ingresos y empleos para miles de personas (CNA, 2021). Los camarones son cultivados en piscinas expuestas, las cuales requieren que las condiciones ambientales sean las adecuadas para lograr tasas óptimas de crecimiento y supervivencia.
El oxígeno disuelto (OD) es un importante parámetro abiótico esencial para muchos procesos fisiológicos en los camarones, que incluyen la respiración, inmunidad, muda y crecimiento (Allan y Maguire, 1991; Ulaje et al., 2020; Wei et al., 2009).
Uno de los principales desafíos que enfrentan los productores de camarón, es la caída de oxígeno durante los ciclos de cultivo, pudiendo alcanzar concentraciones tan bajas como <1.5 mg L-1, considerados críticos (Chen, 1984; Guerrero-Galván et al., 1999). Estas condiciones generan estrés en el organismo, lo cual afecta su rendimiento óptimo e influye en la incidencia y prevalencia de las enfermedades (Alonzo et al., 2017; Muniesa et al., 2017). Por esta razón, el control de los niveles de oxígeno de las piscinas camaroneras es fundamental para mantener la salud y la productividad del cultivo.
El bajo nivel de OD es la principal variable limitante de la calidad del agua en la acuicultura intensiva (Boyd, 1989). En exposición prolongada, a bajas concentraciones de oxígeno, los organismos utilizan sus mecanismos de adaptación para mantener niveles normales de actividad para la búsqueda de alimento y la reproducción. Según Frey (1947), el OD es un factor metabólico regulador en los organismos acuáticos. OD puede limitar la capacidad metabólica y la producción de biomasa. En general, los camarones peneidos son oxireguladores dentro de un limitado intervalo de OD (Villarreal et al., 1994, Villarreal y Ocampo, 1993).
Por otro lado, la producción de OD está determinada por la presencia de microalgas a través de la fotosíntesis, el uso de aireadores y el recambio de agua (Boyd y Tucker, 1998). En promedio, la óptima concentración de OD se encuentra entre 4.4 y 8.6 mg L-1 (Chakravarty et al., 2016; Chen, 1984), donde la solubilidad del oxígeno va a depender también de la salinidad y la temperatura del agua (Boyd y Tucker, 1998).

Las caídas de oxígeno son evitadas por los camaroneros debido a la incidencia directa sobre el consumo del alimento que, en tiempo prolongado, disminuye el crecimiento del camarón e incrementa el factor de conversión alimenticia (FCA) si no se considera este parámetro al momento de alimentar. De allí, la importancia de investigar acerca del efecto de la composi-

ción nutricional como factor influyente en la fisiología del camarón.
Descripción de lo realizado
Se colocaron camarones
Litopenaeus vannamei, con peso inicial de 5.29 ± 0.02 g, en 24 tanques circulares de 500 L, donde se distribuyeron seis tratamientos por cuadruplicado a una densidad de 18 camarones m-2. Luego de un período de aclimatación a las condiciones del estudio, en los que se incluían niveles óptimos de oxígeno de 6 mg L-1, los camarones fueron alimentados manualmente con las dietas experimentales a saciedad tres veces al día: 09h00, 12h00 y 17h00 durante 8 semanas. Una vez al día, el alimento no consumido fue recolectado, secado y, posteriormente, pesado para calcular el FCA. Los camarones fueron alimentados con una dieta experimental nutricionalmente completa (AC) y otra con menor valor nutricional (AMN), cada una enfrentada a períodos de reducción de oxígeno (<2 mg L-1) durante 4 horas consecutivas una vez a la semana, en diferentes períodos que comprendieron las últimas 2 y 4 semanas de estudio, como se detalla en la Tabla 1.
Al final de la prueba, los camarones fueron contados y pesados después de un día de ayuno, para limpiar el intestino del camarón. Los camarones se capturaron con una red y se recolectaron en baldes (un balde por tanque) que representaban cada réplica de los tratamientos; luego, fueron secados
con papel absorbente y pesados de manera individual. A continuación, se evaluaron estadísticamente el peso final, la supervivencia, la biomasa final, la tasa de crecimiento específica (TCE) y FCA, primero mediante un ANOVA de dos vías para encontrar diferencias entre tipos de alimentos, niveles de restricción de oxígeno, además de estimar la existencia de interacciones, y posteriormente con ANOVA simple y prueba post-hoc LSD Fisher para encontrar diferencias significativas (p < 0.05) entre los tratamientos. Todos los análisis se realizaron con Statgraphics® Centurion™ XVII (®Copyright 19822014 Statpoint Technologies, Inc.).
Resultados del estudio
El efecto de las restricciones de oxígeno y el tipo de alimento se presentan en la Tabla 2. Un análisis ANOVA dos vías reveló que existe una diferencia significativa (p < 0.05) en el peso final, TCE dada por el tipo de alimento, las restricciones de oxígeno y las interacciones de estas dos variables.
Con el objetivo de encontrar diferencias entre los tratamientos, se realizó un análisis ANOVA de una vía y, posteriormente, la prueba post-hoc LSD Fisher se llevó a cabo para cada uno de los parámetros zootécnicos que mostraron diferencias estadísticas entre tratamientos.
En la Tabla 3 se observa el efecto que tuvo la reducción de OD en las poblaciones de camarón a lo largo del tiempo. Aquellos cama-
El control de los niveles de oxígeno de las piscinas camaroneras es fundamental para mantener la salud y la productividad del cultivo.
rones alimentados con un misma dieta crecieron de forma similar hasta ser expuestos a caídas de oxígeno durante 2 semanas; mientras que, si se prolongaban a 4 semanas consecutivas, más pronunciada fue la disminución (11%) en rendimiento que se observaba en los camarones alimentados con un alimento completo (AC), comparado con el otro de menor valor nutricional que disminuyó a un 3% con respecto a aquellos camarones que soportaron bajas de oxígeno durante 2 semanas, lo que indicaba que el camarón no lograba sacar el máximo provecho del alimento con mayor contenido nutricional por las continuas caídas de oxígeno. Ocampo et al. (2000) estudiaron los efectos del OD y la temperatura en Farfantepenaeus californiensis, los cuales fueron mantenidos en niveles de oxígeno entre 5.8 a 2.6 mg L-1 y encontraron que el menor crecimiento se obtenía en el nivel más bajo de oxígeno. Estos autores indicaron que los niveles bajos de oxígeno deprimían significativamente el crecimiento. Estos hallazgos concuerdan con los datos presentados en este estudio, el tratamiento de 4 semanas con caídas de OD <2 mg L-1, mostró que los organismos no son capaces de obtener suficiente energía de los alimentos y metabolizar el efecto limitado sobre el nivel crítico de OD.

Los datos de supervivencia no presentan una relación con el tiempo de restricción de oxígeno a los niveles ensayados, tampoco se detectaron tendencias por tipo de alimento durante estas semanas.
Aunque no se detectaron diferencias estadísticas (p > 0.05) en cuanto a eficiencia alimenticia entre tratamientos, una tendencia al aumento del FCA sí fue observada cuando el nivel de OD se restringió en un período de 4 semanas, comparado con la restricción en 2 semanas (Tabla 3). Resultados similares en términos de eficiencia de conversión alimenticia fueron reportados por Wei et al. (2009) en Fenneropenaeus chinensis a niveles de OD de 2 mg L-1. Por otro lado, Allan y Maguire (1991) en Penaeus monodon enfrentado a diferentes niveles de estrés por niveles de

El oxígeno disuelto puede limitar la capacidad metabólica y la producción de biomasa.
OD (0.5 o 1.0 mg O2 L-1) y tiempos de exposición de 4, 8 y 12 h, no observaron diferencias estadísticas en el FCA. Estas diferencias pueden deberse a las distintas especies estudiadas, ya que cada especie de camarón tiene su propia tasa de consumo de oxígeno (Rosas et al., 2001).

Cuando se analizó la biomasa ganada (Figura 1), no se observaron diferencias significativas (p > 0.05) entre tratamientos; sin embargo, cuando el oxígeno fue restringido en 2 semanas, un incremento del 18% fue observado usando alimento AC en comparación al alimento AMN. Una restricción más prolongada a 4 semanas, afectó negativamente la ganancia en biomasa; bajo
estas circunstancias, los camarones mantenidos con el alimento completo AC, se vieron afectados al reducir su rendimiento al 8% en comparación con aquellos alimentados con la dieta de menor contenido nutricional. Según Fry (1947), el OD es un factor metabólico regulador en los organismos acuáticos. OD puede limitar la capacidad metabólica y la producción de biomasa.

Se observaron diferencias estadísticas (p > 0.05) cuando se analizaron los datos de TCE correspondientes a las semanas en las que se restringió el oxígeno (Figura 2). La tasa más alta se consiguió con el alimento nutricionalmente completo en el periodo corto de restricción (2 semanas), mientras que, a mayor
tiempo de restricción (4 semanas), la tasa de crecimiento con alimento AC dio un menor valor, muy similar a la alcanzada por el alimento AMN.
En el presente estudio, las restricciones temporales de oxígeno sugieren que existe un 12% de mejor rendimiento del alimento nutricionalmente completo en términos de peso final y TCE comparados con el alimento de menor valor nutricional, hasta cuando hubo restricciones de OD en las últimas 2 semanas. Sin embargo, esta diferencia en peso final cayó al 3% cuando las restricciones temporales de OD fueron durante las últimas 4 semanas del ensayo de alimentación. Esto indicaría que, las exposiciones crónicas a bajas concentraciones no letales de OD por pocas horas afectan el rendimiento de L. vannamei, al destinar más energía para el balance bioenergético y trabajo metabólico que para el crecimiento, como por ejemplo, concentraciones de OD <2 mg L-1 por períodos de 4 horas una vez a la semana, no se traducen necesariamente en mortalidad. No obstante, los efectos se hacen evidentes en los parámetros zootécnicos y, por ende, en la rentabilidad del cultivo, más aún cuando se está suministrando un alimento de mayor valor nutricional.
Carlos
Guayas
Innovation
cesar.molina@skretting.com
Las

Los datos de supervivencia no presentan una relación con el tiempo de restricción de oxígeno a los niveles ensayados, tampoco se detectaron tendencias por tipo de alimento durante estas semanas.
La elevada demanda de fuentes proteicas ha llevado a recurrir a fuentes no convencionales. La reutilización de los subproductos bovinos representa una oportunidad para crear diferentes ingredientes destinados a la formulación de dietas para el camarón blanco Litopenaeusvannamei
Por: Redacción de PAM*
La elevada demanda de fuentes proteicas ha llevado a utilizar fuentes no convencionales, como la harina de pescado (FM, por sus siglas en inglés). Sin embargo, la harina de subproductos avícolas (PBM) ha ido sustituyendo progresivamente a la FM con excelentes resultados, provocando un aumento de su demanda y, en consecuencia, de su precio. También existen otras fuentes de residuos que podrían aprovecharse, como por ejemplo, la harina de subproductos bovinos (BBM), la cual es una fuente de proteína que contiene alrededor del 50% de proteína bruta y 10% de grasa bruta, lo que permite su uso como alternativa no solo a la FM, sino también a la PBM, en dietas para Litopenaeus vannamei.
La harina de subproductos avícolas es el principal producto de extracción de grasa animal que se vende en el mercado. Sin embargo, su demanda crece en exceso por ser el principal ingrediente proteínico de la mayoría de los alimentos fabricados para la producción animal, en particular, los destinados a las mascotas y la acuicultura. Aunque la industria avícola crece de forma constante, lo hace en una magnitud diferente a la necesaria para cubrir el mercado.
Las harinas de carne y huesos de bovino provienen de los residuos de la producción animal, no aptas para el consumo humano directo,
específicamente del ganado vacuno. La BBM se procesa de forma similar a la PBM, y representa más del 10% del total de la materia prima destinada a la producción de carne para consumo humano.
Con base en las oportunidades, que representa la reutilización de los subproductos bovinos, para crear una cartera de diferentes ingredientes para la formulación de alimentos acuícolas, la presente investigación tiene como objetivo evaluar el efecto de la sustitución gradual de PBM por BBM en la supervivencia, el crecimiento y los parámetros bioquímicos de la hemolinfa del L. vannamei
Un lote de 10,000 camarones blancos, L. vannamei , se transportó a las instalaciones del Instituto de Investigaciones Oceanológicas de la Universidad Autónoma de Baja California (IIO – UABC); los juveniles de L. vannamei fueron proporcionados por el criadero comercial FITMAR en Sinaloa, México, y caracterizados para representar una línea genética mexicana resistente a patógenos locales. A su llegada al IIO, se recibieron en un sistema de recirculación compuesto por dos tanques circulares de

Efecto de la sustitución de harina de subproductos avícolas por harina de subproductos bovinos en el rendimiento global del Litopenaeusvannamei
1,000 L, una bomba, un biofiltro y un skimmer de proteínas.

Se formularon cuatro dietas, una de Control [BBM (0%)] y tres con diferentes niveles de inclusión de BBM: L-BBM [baja inclusión (13.6%)], M-BBM [inclusión media (27.2%)] y H-BBM [alta inclusión (40.7%)]. Todas contenían un 46.5% de proteína cruda (PC) y un 8.5% de grasa cruda (GC), empleando BBM en sustitución de PBM en una formulación completamente libre de pescado, usando aceite de microalgas y colesterol para alcanzar los niveles óptimos (Tabla 1). El aceite de microalgas contenía un 17% de ácido docosahexaenoico (DHA, por sus siglas en inglés), y se añadió a partes iguales a cada dieta.
Se analizó la composición aproximada de todas las dietas experimentales en muestras triplicadas
(Tabla 1). En resumen, el peso seco de las dietas se determinó secando las muestras a 60ºC durante 24 h. Las muestras se incineraron en un horno a 550ºC durante 6 h para determinar las cenizas. A continuación, se analizó la proteína bruta por el método micro-Kjeldahl, y se calculó el contenido de proteína por conversión de nitrógeno, y el contenido en lípidos a través del método Soxhlet, con éter de petróleo como disolvente portador.
La digestibilidad aparente se determinó utilizando la ceniza insoluble en ácido como marcador interno. Se determinó el contenido de cenizas insolubles en ácido de las dietas experimentales y de las heces recogidas durante el bioensayo.
Se analizaron los ácidos grasos de las dietas experimentales y de los tejidos musculares y del hepatopáncreas, según la metodología adaptada de Folch et al. (1957), empleando diclorometano en lugar de cloroformo.

La composición aproximada de las dietas experimentales se muestra en la Tabla 1. Los contenidos de proteína bruta y grasa fueron de 46.0-47.7% y 8.5-9.1%, respectivamente. El contenido en cenizas aumentó a medida que se incluía la BBM, desde 8.8 en el grupo Control hasta 16.7 para la H-BBM; mientras que, el contenido de ácidos grasos de las dietas (Tabla 2) mostraron diferencias aparentes en ciertos ácidos grasos, disminuyendo el ácido linoleico a medida que se incorporó la BBM.
En cuanto al rendimiento global, se observaron diferencias significativas en la supervivencia; donde la mayor supervivencia se presentó con la dieta Control (100%), la cual disminuyó uniformemente hasta 88.9 ± 4.6% para el H-BBM (p < 0.05). Se registraron diferencias significativas en todos los parámetros respecto a los tratamientos. Tras siete semanas de procedimiento experimental, el rendimiento global
arrojó diferencias. El tratamiento H-BBM presentó la mayor tasa específica de crecimiento (SGR, por sus siglas en inglés) significativo (3.43 ± 0.09%/día) y coeficiente térmico de crecimiento (TGC) (0.44 ± 0.016). Sin embargo, el nivel más alto de BBM resultó en el factor de conversión alimenticia (FCR) más bajo (1.51 ± 0.12) (p < 0.05).

El aumento relativo de peso (%) fue significativamente mayor para el tratamiento H-BBM (457.05 ± 27.0) en comparación con el Control (258.6 ± 6.6). Además de la prueba ANOVA, se realizó una prueba polinómica para observar la correlación entre el rendimiento global y los tratamientos dietéticos, mostrando una baja correlación entre el índice hepatosomático (HSI, por sus siglas en inglés) y los tratamientos dietéticos (R2 = 0.245), una correlación media entre los tratamientos y el peso final (R2 = 0.478), el SGR (R2 = 0.419) y el FCR (R2 = 0.455) (Figura 1).
Esta investigación, ha demostrado que la BBM puede sustituir a la PBM en las dietas para camarones, mejorando el rendimiento global. Los resultados obtenidos son significa-
tivos, considerando la existencia de otras materias primas que permiten reducir los costos, sin afectar la calidad de la producción de camarón, mediante el uso de BBM en su alimentación. Además, la BBM, al igual que la PBM, proviene de procesos
de rendering de la producción de animales terrestres, lo que representa una contribución al objetivo de sostenibilidad de los alimentos acuícolas y una economía circular, reduciendo potencialmente la huella de carbono de los alimentos.

Se infiere que la respuesta favorable de los alimentos con altos porcentajes de inclusión de BBM en los camarones se debe a la alta calidad de los nutrientes, contrariamente a informes anteriores sobre camarones y algunas especies de peces alimentados con BBM.
Los resultados sobre los porcentajes de acumulación de ácidos grasos en el hepatopáncreas de los organismos, sugieren que el L. vannamei puede asimilar eficientemente ácidos grasos mono y poliinsaturados en porcentajes superiores respecto al PBM de la dieta Control.
Se observó que el rendimiento mejoró significativamente, con niveles crecientes de inclusión de BBM. Sin embargo, si la tasa de crecimiento no alcanzó el crecimiento deseable esperado, se debe tener en cuenta que los camarones se cultivaron a 27.8ºC. Además, los camarones del presente estudio provienen de un proyecto de línea genética mexicana, elegida para hacer frente a los patógenos en las costas mexicanas. No obstante, el nivel más alto de inclusión de BBM se comporta mejor que los del grupo Control.
Un alto contenido en cenizas podría afectar negativamente a la estabilidad hídrica de la dieta. Considerando que el grupo de tratamiento H-BBM presentó un mayor índice de conversión alimenticia, no se puede especular sobre la estabilidad de la dieta.
Por lo tanto, se infiere que la respuesta favorable de los alimentos con altos porcentajes de inclusión de BBM en los camarones se debe a la alta calidad de los nutrientes. Araújo et al. (2019) concluyeron que la combinación de grasa de vacuno con aceite de microalgas daba lugar a un mejor rendimiento que el uso de aceite de pescado en las dietas de camarones, y el aceite de microalgas
resultaba una combinación más económica.
El camarón no tiene la capacidad de sintetizar ácidos poliinsaturados de cadena larga (LC-PUFA, por sus siglas en inglés). Chen et al. (2014) señalan que se deben incluir ácidos eicosapentaenoico (EPA) y docosahexaenoico (DHA) cuando los camarones se cultivan a salinidades superiores a 20 ppm. Las dietas utilizadas en el presente estudio fueron formuladas con DHA, y se observó que los porcentajes de ácidos grasos en el hepatopáncreas son estadísticamente diferentes (p < 0.05) en ácido araquidónico (ARA), EPA y DHA entre tratamientos. Adicionalmente, la acumulación de LC-PUFA aumentó, correlacionándose de manera directa con la inclusión de DHA, indicando que la acumulación selectiva juega un papel esencial en la acumulación de PUFA.
En cuanto al resto del contenido de ácidos grasos, la reducción significativa de los ácidos grasos n6, en particular del ácido linoleico, refleja su menor contenido en la BBM, 17.1 mg/dL, y todavía no hay ni una sola prueba de que valores de 40.8 mg/ dL en camarones alimentados con H-BBM, como los registrados en este estudio, puedan provocar problemas fisiológicos.
En conclusión, los resultados de esta investigación proporcionan una clara evidencia de que el camarón blanco, L. vannamei , puede ser alimentado con dietas basadas en BBM en sustitución de PBM, sin afectar el rendimiento del crecimiento y la salud, en dietas libres de FM. La inclusión de BBM mejoró los porcentajes de digestibilidad aparente de los organismos, superando los rendimientos productivos de la PBM. Los resultados obtenidos sobre los porcentajes de acumulación de ácidos grasos en el hepatopáncreas de los organismos sugieren que L. vannamei puede asimilar eficientemente ácidos grasos mono y poliinsaturados en porcentajes superiores respecto al PBM de la dieta Control. Sin embargo, la química de la hemolinfa muestra que la dieta H-BBM dio lugar a una mayor acumulación de colesterol, un nutriente esencial del camarón.
Las referencias y fuentes consultadas por el autor en la elaboración de este artículo están disponibles bajo petición previa a nuestra redacción.
Esta es una versión resumida desarrollada por el equipo editorial de Panorama Acuícola Magazine del artículo “EFFECT OF SUBSTITUTION OF POULTRY BY-PRODUCT MEAL BY BOVINE
BY-PRODUCTMEAL ON OVERALL PERFORMANCE FOR LITOPENAEUS VANNAMEI” escritoporLÓPEZ-ORTIZ,E.-Universidad AutónomadeBajaCalifornia;ARAMBULMUÑOZ,E.-CONACYT;TINAJERO,A.,BASÍLIODEL RIO-ZARAGOZA,O.,GALINDO-VALDEZ,L.yVIANA, M.-InstitutodeInvestigacionesOceanológicas, UniversidadAutónomadeBajaCalifornia. La versión original, incluyendo tablas y figuras, fue publicada en MAYO de 2023 en ANIMAL FEED SCIENCE AND TECHNOLOGY. Se puede acceder a la versión completa a través de https://doi.org/10.1016/j.anifeedsci.2023.11568.



La alimentación en la cría de camarones representa alrededor del 50% de los costos de producción, por lo tanto, debe ser la adecuada para garantizar el buen crecimiento y reproducción de los organismos de cultivo y un producto de excelente calidad para el consumidor final. MegaSphe® ofrece una combinación única de características y beneficios para larvicultura y precría de camarones, asegurando una alta estabilidad y calidad de los nutrientes del alimento y muy bajos niveles de lixiviación.

El incremento de la demanda de pescado, como fuente de alimento, es una consecuencia del crecimiento generalizado de la población. En este sentido, el sector acuícola juega un papel fundamental, ya que está categorizado como la fuente más importante de productos acuáticos para el consumo humano, y el pronóstico es que siga creciendo durante los próximos años. En particular, la cría de camarones tiene el potencial ideal para responder a las demandas de alimentación y nutrición de la humanidad. Según Informes de Expertos, el mercado latinoamericano de camarones alcanzó un valor de alrededor


La lixiviación representa uno de los principales problemas en el cultivo de camarones, ya que la ingesta de nutrientes consumidos y utilizados no cumple con el nivel que, en teoría, debería suministrarse con el alimento para satisfacer sus requerimientos nutricionales.

de USD 2.08 mil millones en el año 2021, y se espera que, entre 2023 y 2028, el mercado objetivo crezca a una tasa anual compuesta de 7.12%. Un aspecto clave en la industria acuícola es la alimentación, la cual puede llegar a significar más del 50% de los costos directos de producción. En el caso específico de los camarones, estos tienen un comportamiento de alimentación muy singular, caracterizado por su lentitud. Al ser masticadores externos, mordisquean los alimentos muy lentamente, lo que resulta en un tiempo de permanencia prolongado del alimento peletizado en el agua. Como consecuencia, los nutrientes presentes en el alimento se lixivian o se disuelven en el agua.
La lixiviación representa uno de los principales problemas en el cultivo de camarones, ya que la ingesta de nutrientes consumidos y utilizados no cumple con el nivel que, en teoría, debería suministrarse con el alimento para satisfacer sus requerimientos nutricionales. Al no cumplirse los requerimientos nutricionales, por el desbalance en la dieta, se afecta el crecimiento de los camarones, así como otros parámetros de productividad. Además, la calidad del agua se ve afectada de manera negativa por la lixiviación, y el exceso de compuestos nitrogenados que se generan.
Por otra parte, la producción comercial de camarón se basa en la siembra de postlarvas, que consiste en la crianza de larvas planctotróficas que pasan por varios estadios, los cuales poseen distintas estrategias de alimentación. De esta manera, la larvicultura tiene como reto la producción de organismos semejantes a los existentes en la naturaleza, aunque la alimentación y las enfermedades son factores clave, debido a que pueden ocasionar una alta tasa de mortalidad. La alternativa para controlar estos factores, es el uso de alimento artificial de alta calidad con capacidad para mantener un ambiente saludable, reducir el riesgo de enfermedades y permitir una sustancial disminución en los altos costos del alimento vivo que, a menudo, presenta una alta variabilidad nutricional.
MegaSphe® es un alimento de alta calidad para larvicultura y precría de camarones, elaborado mediante un proceso de microextrusión fría seguido de esferización.
a que las larvas de camarón no tienen la capacidad de digerir ingredientes de origen vegetal terrestre.
9 Producido a baja temperatura, lo cual garantiza la integridad de nutrientes, vitaminas y minerales.
MegaSphe® está disponible en tamaños de < 75 µm, 75-100 µm, 100-150 µm, 150-250 µm, 250-350 µm, 350-500 µm, 500-800 µm y 800-1,200 µm, en las siguientes presentaciones:
9 Envases de 1 kg: (< 75µm, 75-100 µm, 100-150 µm)
Con el avance de la industria alimenticia en acuicultura, se han desarrollado diferentes tipos de alimentos para disminuir los problemas de lixiviación y estabilidad, como microcápsulas, alimento microligado y microcubierto, además de lipoesferas hidroestabilizadas y microemulsiones estables. Cada vez más, las actividades de investigación y desarrollo se centran en la búsqueda de ingredientes digeribles y asimilables que promuevan “un ambiente amistoso” con las larvas, sin olvidar el aspecto económico, estableciendo el uso proporcional del alimento y el cuidado del medio ambiente.
Megasupply es una empresa dedicada exclusivamente a brindar productos alimenticios, probióticos, insumos, equipos y asesoría al mercado acuícola. Esta empresa ofrece a sus clientes, socios y proveedores, el valor agregado de contar con un personal técnico de formación universitaria en el área de acuicultura y con experiencia en producción acuícola.
MegaSphe®: alimento de tecnología avanzada de Megasupply MegaSphe® es un alimento de alta calidad para larvicultura y precría de camarones, elaborado mediante un proceso de microextrusión fría seguido de esferización. Esta avanzada tecnología asegura alta estabilidad y calidad de los nutrientes del alimento y muy bajos niveles de lixiviación.
9 Incluye MegaAcidG® y PromegaBiotic f®PF.
9 Alimento de alta digestibilidad. Solo contiene proteína animal de origen marino, su digestibilidad de proteína en larvas de camarón supera el 95%, mientras que en la mayoría de las dietas secas es del 60% al 80%, debido

9 Mejor calidad de agua, debido al menor nivel de alimento no digerido.
9 Excelentes resultados de producción y protección de salud animal por la inclusión de ácidos orgánicos y probióticos de alta tecnología.
En la formulación de MegaSphe® se emplean ingredientes de alta calidad, entre los que se encuentran proteínas de origen marino, aceite de origen marino, lípidos olefínicos, nucleótido de levadura, premezcla mineral, carbonato de calcio, ácidos orgánicos (MegAcidG®), premezcla vitamínica y probióticos (PromegaBiotic f®PF) (Tabla 1).
Con la finalidad de garantizar el funcionamiento óptimo del producto, se recomienda mantener las siguientes condiciones de almacenamiento:
9 Conservar el empaque cerrado, en un lugar seco y fresco.
9 Temperatura de almacenamiento recomendada: entre un mínimo de 5°C y un máximo de 25°C.
9 Evite congelar o almacenar a temperaturas superiores a 40° C.
9 Vida útil: 2 años si se almacena en las condiciones recomendadas.
En cuanto al uso y aplicaciones del producto, se debe mezclar la dosis de alimento con agua limpia y distribuir por todo el tanque, dividir, la cantidad sugerida, entre 4 y 6 raciones al día. Además, se debe evitar la sobrealimentación y subalimentación mediante la observación frecuente de la salud larval y el remanente de alimento en el tanque previo a la próxima alimentación. Se sugiere alimentar de 4 a 6 veces al día de Z1 a PL1 y de 6 a 24 veces al día de PL2 a PL26.
9 Envases de 3 kg: (150-250 µm, 250-350 µm)
9 Envases y bolsas de 10 kg, 12 kg y 20 kg: (250-350 µm, 350-500 µm, 500-800 µm, 800-1,200 µm)
Megasupply es una empresa cuya misión es ser un socio estratégico de sus clientes, proveedores y empleados, generando valor a través de la distribución de productos alimenticios, probióticos, insumos, equipos y asesoría al mercado acuícola. En su categoría de alimentos, brinda productos de excelente calidad, con ingredientes patentados, dirigidos a las características específicas y requerimientos de cada especie y proceso de cultivo.

MegaSphe® es un alimento de alta calidad para larvicultura y precría de camarones, elaborado mediante un proceso de microextrusión fría, seguido de esferización. Esta avanzada tecnología asegura una alta estabilidad y calidad de los nutrientes del alimento y muy bajos niveles de lixiviación.
Esta es una versión resumida desarrollada por el equipo editorial de Panorama Acuícola Magazine del artículo “MEGASPHE® ALIMENTO DETECNOLOGÍA AVANZADA PARA LARVICULTURA Y PRECRÍA DE CAMARONES”escrito por MEGASUPPLY. La versión original, incluyendo tablas y figuras, fue publicada en FICHATECNICA MEGASPHE SHRIMP. Se puede acceder a la versión completa a través de www.megasupply.net.

Los datos de la secuencia de amplicones 16S y el modelado metabólico, basado en el genoma, se combinaron para la aplicación en acuicultura, con el propósito de encontrar biomarcadores nativos que puedan emplearse mejor, para desarrollar formulaciones probióticas, que aprovechen los microorganismos beneficiosos para el cultivo de Penaeus vannamei, al tiempo que limitan el crecimiento de patógenos.
Por: Redacción de PAM*
Con el advenimiento de la secuenciación de alto rendimiento, los conjuntos de datos del metagenoma se han vuelto cada vez más accesibles. El enfoque metagenómico independiente del cultivo ha facilitado un análisis exhaustivo de los datos del microbioma con fines preventivos y de diagnóstico. Incluso, en el sector de la acuicultura, los consorcios microbianos son cruciales para mejorar la sostenibilidad y la productividad de los organismos acuáticos. Diversos factores amenazan la sostenibilidad y el rendimiento de las especies acuícolas, uno de los cuales se relaciona con la infección causada por
microorganismos patógenos. Por lo tanto, comprender los consorcios microbianos esenciales y significativos simplificaría la predicción de la incidencia de enfermedades.
En organismos acuáticos, el enfoque basado en la secuencia de amplicones se ha utilizado para identificar microbiomas, su composición y funciones. El estudio actual se centra en Penaeus vannamei, cuyo cultivo ha aumentado rápidamente para satisfacer la creciente demanda de proteínas comestibles de alta calidad. A pesar de esto, el cultivo de P. vannamei se ve constantemente obstaculizado por factores abióticos y bióticos. Uno de los desafíos se relaciona con las enfer-
medades emergentes causadas por bacterias, virus y hongos, que afectan la sostenibilidad del camarón. Es por ello que, este artículo presenta el resumen de un metaanálisis realizado con la finalidad de lograr una comprensión más sólida y consistente de los estados de salud frente a los estados de enfermedad en P. vannamei
Los datos de la secuencia de amplicón utilizados. para el metaanálisis. se recuperaron de la base de datos NCBI SRA (descargada en septiembre de 2021). Los estudios recolectados se relacionaron con especies de P. vannamei asociadas con una
enfermedad, considerando solo el tejido del huésped o muestras de intestino. Inicialmente, la búsqueda produjo 13 estudios con 838 conjuntos de datos. Sin embargo, se descartaron algunos estudios debido a la falta de información sobre el hábitat.

El conjunto de datos de la enfermedad incluido en este metaanálisis corresponde a eventos de enfermedad de heces blancas (DMA, por sus siglas en inglés), virus del síndrome de la mancha blanca (WSSV) y enfermedad necrótica hepatopancreática aguda (AHPND).

Los estudios disponibles contrastaron en las subregiones del gen 16S rRNA, como V3-V4, V4, V1-V2, V2 mix y V3 mix secuenciados con diferentes plataformas de secuenciación. Debido al número limitado de estudios con metadatos adecuados, no fue posible implementar una tecnología de secuenciación uniforme o una región hipervariable común. Finalmente, se consideraron seis estudios con un total de 259 conjuntos de datos.
Los seis estudios incluyeron datos que abarcaban 259 conjuntos de datos (117 sanos y 142 enfermedades). Los criterios de inclusión para este metaanálisis fueron estudios basados en la secuencia de amplicones sobre P. vannamei en estados sanos y de enfermedad. Para identificar un biomarcador taxonómico potencial, un solo estudio puede no ser suficiente; por lo tanto, se realizó un metaanálisis que podría servir como un biomarcador representativo y biológicamente significativo. Además, se llevó a cabo un enfoque de modelado metabólico, basado en restricciones, para capturar las capacidades metabólicas de los biomarcadores taxonómicos en diferentes entornos nutricionales e inferir las interacciones entre especies. La Figura 1 muestra el flujo de trabajo que describe los pasos clave seguidos en el estudio.
Abundancia microbiana a nivel de filo y género en estados saludable y de enfermedad
Se examinaron los cinco principales filos y géneros dominantes, calculando la abundancia relativa media en conjuntos de datos sanos y de enfermedades. Un filo o género con una abundancia media de ≥ 0.01 se consideró abundante. A nivel de filo, Proteobacteria (62% en estado sano vs. 72% en estado de enfermedad) y Firmicutes (30% en sano vs. 20% en estado de enfermedad) son los principales representantes, seguidos por Bacteroidota, Actinobacteriota y Cyanobacteria en ambos estados según la abundancia relativa media. Cuatro géneros dominaron tanto los estados sanos como los de enfermedad en orden descendente de magnitud, a saber: Vibrio, Candidatus Bacilloplasma, Photobacterium y Shewanella. Sin embargo, la abundancia relativa media de estos géne-
El cultivo de P. vannamei se ve constantemente obstaculizado por factores abióticos y bióticos. Uno de los desafíos se relaciona con las enfermedades emergentes causadas por bacterias, virus y hongos que afectan la sostenibilidad del camarón.
ros fue marginalmente diferente en ambos estados, como se muestra en la Figura 2. Curiosamente, el género Alteromonas se presentó solo en el estado de enfermedad, y el género Acinetobacter fue más abundante en el estado saludable, mostrando una menor abundancia en el estado de enfermedad.
Detección de biomarcadores microbianos en estados saludable y de enfermedad
El análisis discriminante lineal tamaño del efecto (LEfSe, por sus siglas en inglés), de biomarcadores taxonómicos, se llevó a cabo en el conjunto de datos combinado para estimar si había una diferencia significativa en la abundancia relativa entre el estado saludable/enfermedad. LEfSe identificó 32 géneros beneficiosos y 73 géneros de enfermedades como biomarcadores prospectivos con un tamaño de efecto mayor de dos y un valor de p < 0.05. Los cinco principales biomarcadores sanos pertenecían al filo Firmicutes y Proteobacterium, incluidos los géneros Candidatus, Bacilloplasma, Acinetobacter, Exiguobacterium, Lactobacillus y Shimia. Por otro lado, los cinco principales biomarcadores de enfermedades pertenecían al filo Proteobacteria, incluidos los géneros Alteromonas, Photobacterium, Pseudoalteromonas, Halomonas y Marinomonas. La abundancia relativa media correspondiente a los biomarcadores taxonómicos dominantes en el estado saludable y de enfermedad se representa en la Figura 3. Además, fue interesante observar que la mayoría de los biomarcadores de enfermedades identificados pertenecían al filo Proteobacteria.
Las comunidades microbianas naturalmente existentes realizan distintas tareas vitales, como la degradación de la materia orgánica, el reciclaje de los nutrientes y el control del desarrollo de infecciones microbianas (Bentzon-Tilia et al., 2016). Es fundamental comprender el estado de salud y las comunidades micro-
bianas asociadas a la enfermedad, para mantener la salud del huésped. Numerosas investigaciones basadas en la secuencia de amplicones 16S han intentado desentrañar el papel de los microbios, pero los hallazgos extraídos de un estudio pueden no descifrar el espectro completo de microbios responsables de los estados de salud/enfermedad. Por lo tanto, estudiar múltiples estudios en un metaanálisis tiene el potencial de hacer inferencias sobre las características comunes asociadas con la salud del huésped en diferentes hábitats.
Aunque, se reportaron varios trabajos sobre la perspectiva de la salud humana, muy pocos estudios se realizan sobre especies acuáticas, pero no se extendieron para comprender las interacciones metabólicas entre ellas (Cornejo-Granados et al., 2018; Yu et al., 2018). La identificación de biomarcadores taxonómicos en la acuicultura no es nueva; sin embargo, la mayoría de las investigaciones se centran en biomarcadores taxonómicos basados en un solo estudio, lo que implica la necesidad de un análisis mucho más completo.
En este contexto, el presente metaanálisis identificó los biomarcadores taxonómicos centrales que impulsan las diferencias en los estados de salud/enfermedad en P.
vannamei y determinan las interacciones entre especies exhibidas por los biomarcadores microbianos en diferentes entornos de nutrientes. Como un aporte al manejo sostenible de la enfermedad, el objetivo de este estudio es identificar especies autóctonas beneficiosas en P. vannamei esenciales para mantener un buen estado saludable y controlar el crecimiento de especies patógenas.
El estudio identificó Acinetobacter como uno de los géneros prevalentes y dominantes en el estado saludable. Acinetobacter fue previamente detectado y reportado en camarones sanos para ayudar a suprimir bacterias dañinas (Farzanfar et al., 2006). Se informó que los principales géneros revelados en el estado saludable de este estudio fueron Acinetobacter y Candidatus bacilloplasma, los cuales actúan a modo de eje central que conecta la importante población bacteriana en la red del hepatopáncreas de camarón sano (Wang et al., 2020). Además, los géneros Exiguobacterium en estado saludable han mejorado el crecimiento y la supervivencia en P. vannamei y han proporcionado ventajas probióticas (Cong et al., 2017; de Mello Júnior et al., 2021). Los miembros de Lactobacillus identificados en este estudio son probióticos conocidos y han sido ampliamente estudiados por sus

habilidades para mantener la salud animal. Shimia sp, otro género identificado en estado saludable en este análisis, se ha informado que produce metabolitos beneficiosos y degrada las toxinas (Duan et al., 2019).

A pesar de que se encontró Vibrio, en ambos estados, apoyando estudios previos (de Souza Valente et al., 2021; He et al., 2020), se considera como bacteria oportunista y causa enfermedades cuando el organismo se encuentra bajo estrés. En general, los géneros sanos reportados en el presente estudio son comparables con estudios anteriores, lo que confirma la exactitud de este enfoque.
Está bien establecido que los ácidos orgánicos se emplean en la conservación de alimentos, como
aditivos para alimentos y para controlar patógenos (Ng et al., 2017). Aunque muchas especies beneficiosas o probióticas se usan en la acuicultura, la falta de consistencia y rendimiento en diferentes condiciones es una preocupación importante. Dado que las interacciones de las especies microbianas varían en diferentes entornos de nutrientes, es crucial identificar el entorno favorable que controla el crecimiento de las especies de enfermedades. Como resultado, estos hallazgos agregan valor al demostrar que la sacarosa facilita las interacciones parasitarias (es decir, limita el crecimiento de la enfermedad), lo que es consistente con investigaciones anteriores que destacaron el papel de la sacarosa y las especies benefi-
ciosas en la mejora de la calidad de agua, el crecimiento de P. vannamei y la composición microbiana.
Por primera vez, los datos de la secuencia de amplicones 16S y el modelado metabólico basado en el genoma se combinaron para la aplicación en acuicultura, con el propósito de encontrar biomarcadores nativos que puedan emplearse mejor para desarrollar formulaciones probióticas que aprovechen los microorganismos benéficos para el cultivo de P. vannamei, al tiempo que limitan el crecimiento de patógenos. El análisis basado en secuencias de amplicones combinado con el modelado metabólico proporcionó información sobre las interacciones metabólicas y el impacto de los entornos de nutrientes y, finalmente, permitió seleccionar posibles especies benéficas para acelerar los experimentos. Se empleó esta estrategia de combinación para la aplicación de probióticos en acuicultura, la cual se aplicó previamente a la microbiota intestinal humana. Los géneros clave identificados en este estudio podrán usarse para preparar una formulación y reponer los consorcios microbianos sanos. Con el fin de fomentar el cultivo saludable de camarones, estos géneros esenciales pueden reducir la gravedad de las enfermedades eliminando bacterias patógenas oportunistas y potenciando las asociaciones benéficas internas.
La versión informativa del artículo original está patrocinada por: GRUPO GAM.
Esta es una versión resumida desarrollada por el equipo editorial de Panorama Acuícola Magazine del artículo “IN SILICO PREDICTION OF POTENTIAL INDIGENOUS MICROBIAL BIOMARKERS IN PENAEUS VANNAMEI IDENTIFED THROUGH META-ANALYSIS AND GENOME-SCALE METABOLIC MODELLING”escritoporNEELAKANTANTHULASIDEVIKA,VINAYA KUMAR KATNENI,ASHOK KUMAR JANGAM, PANJAN NATHAMUNI SUGANYA,MUDAGANDUR SHASHI SHEKHAR AND KARINGALAKKANDY POOCHIRIAN JITHENDRAN - Central Institute ofBrackishwaterAquaculture,Chennai, India. La versión original, incluyendo tablas y figuras, fue publicada en ENERO de 2023 en ENVIRONMENTAL MICROBIOME. Se puede acceder a la versión completa a través de https:// doi.org/10.1186/s40793-022-00458-6

La vibriosis ha elevado las tasas de mortalidad en cultivos de camarón en todo el mundo. En este artículo se comparten resultados de la efectividad de GPC8TM, potente desinfectante de uso general a base de glutaraldehído, contra Vibrio parahaemolyticus en el cultivo de camarón blanco del Pacífico (Penaeusvannamei).
La vibriosis es una enfermedad bacteriana, causada por cepas patógenas extracelulares de varias especies pertenecientes al género Vibrio. En cultivos de camarón en todo el mundo, la vibriosis ha elevado las tasas de mortalidad, tanto en su fase larvaria como de engorda. En general, los brotes se producen por cambios ambientales que aceleran la reproducción bacteriana, sobrepasando la tolerancia de estos organismos y causando enfermedades.
Se puede presentar una amplia variedad de enfermedades causada por la vibriosis en los camarones: vibriosis oral, vibriosis entérica, diferentes tipos de necrosis, síndrome de la concha suelta (SLSS, por sus siglas en inglés), enfermedad del intestino blanco (WGD); entre otras. Por tanto, es importante la prevención y atención del Vibrio causante de estos padecimientos que afectan la producción de camarón.
El GPC8TM es un potente desinfectante de uso general a base de glutaraldehído, con un amplio espectro de actividad, altamente efectivo contra bacterias, virus y hongos; cuya composición incluye:
9 Glutaraldehído: 12%
9 Amonio cuaternario: 4%
9 Surfactante no iónico: 8%
9 Ácido fosfórico: 8%.
Entre las funciones del GPC8TM se encuentran:
9 Desinfección del agua antes del cultivo.
9 Tratamiento de patógenos durante el cultivo.
9 Eliminación de virus como: el Monodon baculovirus (MBV, por sus siglas en inglés), cabeza amarilla, síndrome de la mancha blanca (WSSV), virus de la necrosis hipodérmica y hematopoyética infecciosa (IHHNV), Síndrome de Taura (TSV), necrosis y bacterias que causan síndrome de mortalidad temprana (EMS). Además, tiene la ventaja de ser compatible con otros productos desinfectantes.
9 Eliminación de vibriosis luminiscente, coloración roja en cola y antenas, manchas negras, pleópodos rojos, enfermedad de branquias negras o enfermedad intestinal.
9 Eliminación de Fusarium, que causa branquias negras en camarones

9 Eliminación de Zoothanium sp, causante de la enfermedad de heces blancas provocadas por Gregarin
En cuanto a su forma de aplicación, depende de la etapa en la cual se encuentre el cultivo: 1) entre dos y tres horas antes del cultivo, para el tratamiento del agua con 0.5-0.8 litros/1,000 m3 (0.5-0.8 ppm); 2) durante el cultivo, se realiza la desinfección regular de patógenos, empleando una proporción de 1 litro/4,000-6,000 m3 (0.17-0.25 ppm) y 3) se continúa la aplicación cada 15 días, hasta la recolección o cose-

cha. En criaderos, se recomienda su uso para la higiene y desinfección de equipos y tanques, en una proporción de 1 litro/100 m3 (10 ppm). La información, que se presenta a continuación, se basa en un reporte desarrollado por el Instituto de Investigación para la Acuicultura No.2 (RIA2, por sus siglas en inglés) y la empresa de productos de higiene y limpieza Evans Vanodine, sobre el efecto del producto GPC8TM en la desinfección contra Vibrio parahaemolyticus en el cultivo de camarón blanco del Pacífico.

La muestra del estudio consistió en ejemplares de P. vannamei PL60, con un peso de 1.5 ± 0.03 g comprados en un criadero de calidad. Los camarones fueron examinados, para garantizar que estuvieran libres de patógenos específicos, antes de liberarlos para el ensayo; mientras que el V. parahaemolyticus se cultivó en el WebLab del RIA2, donde se desarrolló parte del estudio. La otra parte de la investigación, tuvo lugar en estanques de engorda de camarones blancos del Pacífico, en la provincia Bac Lieu.
El estudio se desarrolló en tres fases. La primera, denominada Contenido 1, fue la investigación de la enfermedad que causa anti-Vibrio en camarones in vitro. En la segunda, Contenido 2, se determinó la concentración letal para el 50% de la población (LC50, por sus siglas en inglés) y la capacidad para eliminar V. parahaemolyticus in vivo. Finalmente, la tercera fase, Contenido 3, consistió en determinar la efectividad de los productos cuando se aplican en los estanques de engorda de los camarones blancos del Pacífico.
En esta fase, se empleó el método de difusión (Chythanya et al., 2002). Se seleccionó una colonia de V. parahaemolyticus (inicialmente a -80°C) con un método de incubación de 30°C, 24 h, y se transfirió a 10 ml de caldo de soya tripticaseína (TCBS, por sus siglas en inglés), a una densidad óptica (OD, siglas en inglés) de 600 nm, diluido a 2x108 tb/ml (Figura 1). Las concentraciones de GPC8TM empleadas fueron: 0, 0.25, 5, 10, 20, 40, 60, 80, 100, 200, 500, 1,000 y 10,000 ppm; mientras que las con-
centraciones de GPC8TM empleadas para el cocultivo fueron de: 0, 0.25, 0.5, 1, 5, 10 y 20 ppm.
La Figura 2 muestra los resultados obtenidos con el procedimiento del Contenido 1, donde se puede observar que utilizando el método de cocultivo in vitro ocurre una eliminación de V. parahaemolyticus de 100% para dosis de 10 ppm y 20 ppm del producto GPC8TM

En esta segunda fase, se determinó la concentración letal para el 50% de la población y la capacidad para eliminar V. parahaemolyticus in vivo. El experimento LC50 se llevó a cabo con una salinidad de 15 ppt, en tanques plásticos de 10 L, con una densidad de camarones de 15 ind/tanque (PL60), en 3 réplicas. Las dosis usadas de GPC8TM


fueron de: 0, 5, 10, 20, 30, 40, 50, 100 ppm. Adicionalmente, para la determinación de la densidad de V. parahaemolyticus (VP) causante de LD50 de los camarones blancos del Pacífico, se empleó una salinidad de 15 ppt, en un tanque tipo acuario de 10 L, con una densidad de camarones de 10 ind/tanque (PL60), tres réplicas, a diferentes densidades de VP.
Para la prueba de desinfección in vivo, la salinidad fue de 15 ppt, pH 7, temperatura 28°C, el tanque fue tipo acuario de 150 L, la densidad de camarones de 15 ind/tanque (PL60), tres réplicas. La densidad de VP de 2xLD50 = 2x10 cfu/L, y las dosis de GPC8TM fueron: NT0 (control negativo, sin añadir GPC8TM y VP), NT1 (control positivo, añadiendo VP y sin GPC8TM); NT2 (0.5 ppm), NT3 (1 ppm), NT4 (5 ppm), NT5 (10 ppm) y NT6 (20 ppm). Se monitoreo el total de Vibrio y la tasa de supervivencia de camarón (Figura 3).
En la Figura 4, se observa una mayor tasa de supervivencia de los camarones en la prueba in vivo para concentraciones de 10 ppm y 20 ppm de GPC8TM.

Esta fase del estudio, consistió en determinar la efectividad de los productos cuando se aplican en los estanques de engorda de los camarones blancos del Pacífico. El experimento se realizó de agosto a octubre de 2015, en la provincia de Bac Lieu. Para la preparación del estanque, se drenó el agua y se roció con CaCO3 (100 kg/ha). Después de suplir el agua, se añadió GPC8TM en una concentración de 5 ppm y durante el período de cultivo de 1 ppm. Se tomaron muestras de agua antes y después de 12 horas o 24 horas. Los parámetros analizados fueron: temperatura, pH, demanda química de oxígeno (COD, por sus siglas en inglés), clorofila, amoníaco, nitrito y Vibrio total.
Después de usar GPC8TM para tratar el agua, los resultados mostraron una ligera disminución del pH y una fuerte disminución en COD y clorofila. Esto significa que el GPC8TM puede oxidar materia orgánica y eliminar las microalgas.
La densidad de V. parahaemolyticus disminuyó en 99.1%, con 5 ppm de GPC8TM después de 24 horas, como se muestra en la Figura 5.
Conclusiones
Los hallazgos, de esta investigación, permiten puntualizar las siguientes conclusiones:
9 El método de difusión empleado resultó apropiado: dosis de 10,000 ppm con zona clara de 16.66 mm.
9 Del experimento en cocultivo se obtuvo que las dosis de 5 ppm, 10 ppm y 20 ppm pueden eliminar Vibrio parahaemolyticus desde 75% al 100%.

9 La concentración de GPC8TM que causa 50% de tasa de mortalidad (LC50) en camarones blancos del Pacífico es de 23 ppm.
9 La densidad de V. parahaemolyticus que causa 50% de la tasa de mortalidad (LD50) en P. vannamei se determinó con la dosis de 1x106 cfu/ml VP.
9 En el experimento in vivo, la desinfección de GPC8TM con las dosis de 10 y 20 ppm pueden

eliminar VP durante 6 horas. Después de 6 horas, disminuye el componente activo.
9 Para la preparación de estanques: GPC8TM, en dosis de 5 ppm, se puede usar para eliminar Vibrio total en estanque de camarones blancos del Pacífico.
9 Durante el período de cultivo de P. vannamei: GPC8TM, en dosis de 1 ppm, puede usarse para eliminar Vibrio total.
Esta es una versión resumida desarrollada por el equipo editorial de Panorama Acuícola Magazine del artículo “GPC8 REPORT RIA2 AND EVANS VANODINE INTERNATIONAL PLC”escrito porResearchInstituteforAquacultureN°2. La versión original, incluyendo tablas y figuras, fue publicada en OCTUBRE de 2015 en RESEARCH INSTITUTE FOR AQUACULTURE N°2 and EVANS VANODINE INTERNATIONAL PLC.

La experiencia en Zeigler sugiere que el suministro total de alimento por PL producida, ha aumentado entre un 30 y un 50% en comparación 15 o 20 años atrás. Esta mayor demanda nutricional de las larvas de crecimiento más rápido requiere no solo más alimento, sino también alimentos de mayor calidad.
El cultivo de camarones ha crecido de una manera sin precedentes en las últimas tres décadas, impulsado por el crecimiento de la población y la creciente demanda de fuentes de proteínas más saludables. Cuando se estancó el crecimiento de la oferta de camarones de la pesca de captura, la cría de camarones presentó una nueva oferta sostenible para satisfacer la demanda del mercado. Hoy en día, más de la mitad del camarón consumido a nivel mundial es de cultivo, lo que contribuye con las economías de muchos países. La industria ha evolucionado, desde la simple siembra de postlarvas (PL) capturadas en la naturaleza hasta un ciclo de cultivo más organizado y completamente cerrado. A lo largo de los años, la industria se ha beneficiado de las mejoras genéticas, los avances en la formulación de alimentos, las técnicas de detección de enfermedades y los avances tecnológicos en las prácticas acuícolas. Todas estas mejoras están interconectadas y colectivamente ayudan a respaldar una producción global de camarón más estable.
La mejora genética ha sido uno de los avances más impactantes para el cultivo de camarones y, durante mucho tiempo, ha sido una prioridad para los programas genéticos alcanzar una mayor rapidez en el crecimiento. Los programas de selección genética pueden producir una mejora del 8 al 10%, por gene-
ración, en las tasas de crecimiento del camarón. Estas mejoras se manifiestan no solo en la etapa de engorda, sino también en las larvas de camarón. En muchos laboratorios, los pesos de cosecha típicos de las PL han aumentado de 2.5 a 3.5 mg hace 15 a 20 años, a 4 a 5 mg en la actualidad.
A medida que aumentan las tasas de crecimiento, la demanda total de alimento también se expande para cumplir con los requisitos nutricionales más altos de los organismos. La experiencia en Zeigler sugiere que el suministro total de alimento
por PL producida, ha aumentado entre un 30 y un 50% en comparación 15 o 20 años atrás. Esta mayor demanda nutricional de las larvas de crecimiento más rápido requiere no solo más alimento, sino también alimentos de mayor calidad. En este contexto, los precios de PL se han mantenido relativamente estables, mientras que otros costos de producción, como los de mano de obra y energía, han aumentado. En consecuencia, la alimentación representa, para muchos gerentes de laboratorios, un costo que se debe minimizar.

Efectos del amonio en el crecimiento
Tratar de apoyar el crecimiento más rápido de los camarones con alimentos económicos y de baja calidad, no es una estrategia sostenible. Los alimentos de baja calidad se convierten en biomasa de camarones de manera menos eficiente, lo que resulta en la acumulación de desechos orgánicos y amoníaco en el sistema de cultivo. El amonio es tóxico para las larvas de camarón y afecta negativamente la salud, la supervivencia y el crecimiento de las larvas. La investigación en el Centro de Investigación de Acuicultura Zeigler (Z-ARC, por sus siglas en inglés) ha demostrado que los niveles de amonio tan bajos como 1 mg/L tienen un impacto negativo en el peso de cosecha de las PL (Figura 1).
La investigación en Z-ARC se ha centrado en desarrollar dietas larvales de alta calidad, capaces de maximizar el potencial de crecimiento de las larvas de camarón y minimizar los impactos negativos en la calidad del agua. El enfoque de Zeigler, es hacer coincidir estrechamente el perfil nutricional del alimento con los requisitos nutricionales de los camarones, empleando ingredientes de alta calidad con alta digestibilidad. Sobre la base de 40 años de experiencia en nutrición de larvas de camarón, los investigadores de Z-ARC dedicaron tres años probando ingredientes y formulaciones en un sistema de investigación de cría de larvas altamente replicado, para identificar los ingredientes más digeribles y optimizar el perfil nutricional de una nueva dieta para misis y estadios de postlarvas de camarón. El resultado de este esfuerzo fue Z ProTM
Un concepto importante, aprendido durante el desarrollo de Z ProTM, es que los niveles más altos de proteína no siempre se tradu-

cen en un mejor desempeño de los camarones. La eficiencia proteica también es fundamental para el desempeño del alimento. La eficiencia proteica son los gramos de larvas producidas por gramo de proteína alimentada. Si se cumplen los requisitos de aminoácidos de las larvas, un alimento con un contenido de proteína más bajo, pero una mayor eficiencia de proteína, a menudo superará a las dietas con niveles de proteína más altos. Muchos gerentes de laboratorios, mientras intentan proporcionar la mejor dieta para sus camarones, al menor costo, seleccionan dietas ricas en proteínas y de menor costo bajo el supuesto de que los niveles más altos de proteína respaldarán un mayor crecimiento. Este no es necesariamente cierto. Por lo general, las dietas altas en
proteínas generan más amoníaco que las dietas bajas en proteínas; razón por la cual las tasas de crecimiento de las dietas con niveles más altos de proteínas suelen ser menores que las de aquellas con niveles más bajos de proteínas, en especial, las formuladas con niveles óptimos de aminoácidos y elaboradas con ingredientes altamente digeribles. Este concepto se ilustra en la Figura 2. Los beneficios de alimentar con dietas larvales de alta calidad no se limitan al laboratorio. Las postlarvas más grandes y robustas, cultivadas con alimentos de calidad, se desempeñan mucho mejor en las fases de producción posteriores que las postlarvas más pequeñas y más débiles cultivadas con alimentos económicos. En un estudio realizado en un laboratorio comercial

Z ProTM como una parte importante de un protocolo puede contribuir a una reducción de las tasas de alimentación totales de hasta un 43%.
en México, un grupo de larvas recibió Z ProTM como alimento seco principal, mientras que un grupo de control recibió el coctel estándar del laboratorio de alimentos secos de la competencia. Luego, los dos grupos de PL se sembraron en raceways a densidades similares. Ambos grupos de tanques de raceways fueron alimentados y manejados igual; sin embargo,
las supervivencias en los raceways sembrados con PL alimentados con Z ProTM en los tanques de cultivo fueron significativamente más altas que las supervivencias en los raceways sembrados con las PL alimentadas con el coctel de dietas secas (Tabla 1).


Esos laboratorios, que consideran el alimento como una inversión y se concentran en evaluar el alimento
en función de su eficiencia de conversión, obtendrán la mayor cantidad de beneficios. Es importante reconocer que los protocolos de coctel que mezclan dietas, de alta calidad con alimentos de baja calidad, están diluyendo todo el potencial de productos de alto rendimiento. Por lo tanto, Zeigler recomienda encontrar la mejor combinación de equilibrio con Z ProTM
Los productores más exitosos son aquellos que se enfocan en el desempeño del camarón para lograr la rentabilidad, sin sacrificar nunca el desempeño mientras controlan los costos.
En pruebas en laboratorios comerciales, el personal técnico de Zeigler ha demostrado que la alimentación de Z ProTM, como una parte importante de un protocolo, puede contribuir a una reducción de las tasas de alimentación totales de hasta un 43% en comparación con el protocolo de control con dietas de la competencia. La reducción en las tasas de alimentación, permitida por la alimentación con una dieta más digerible, resultó en niveles más bajos de amonio y menos intercambio de agua, lo que resulta en mayores ganancias.

Los alimentos que respaldan una mayor supervivencia pueden mejorar la rentabilidad del laboratorio, incluso si estos alimentos son más caros. Una calculadora de economía para laboratorios, desarrollada por Zeigler, se basa en datos recopilados a nivel mundial y sugiere que una mejora del 5% en la supervivencia genera un aumento del 17% en las ganancias del laboratorio, debido al aumento de los ingresos de las ventas de PL. En la prueba en laboratorio comercial mencionado anteriormente, el costo de la dieta Zeigler fue más de un 50% más alto que el costo de los alimentos mixtos, pero la ganancia por tanque fue un 9% mayor.


El uso de líneas genéticas de camarón de crecimiento más rápido es fundamental para el éxito de la industria camaronera. Para que la industria aproveche al máximo el potencial genético de los camarones, es esencial que los laboratorios inviertan en alimentos de calidad que respalden el máximo crecimiento y minimicen los efectos negativos de los altos niveles de amoníaco. Las dietas de laboratorio de calidad son una inversión valiosa, cuya ganancia se genera tanto en la cosecha de PL como en la granja. Cuantos más laboratorios den prioridad a la inversión en dietas de alta calidad para el bienestar de sus cultivos, mayor será el beneficio para toda la industria. A medida que aumentan las presiones sobre los precios del camarón, la eficiencia de la producción debe mejorar. Los productores más exitosos son aquellos que se enfocan en el desempeño del camarón para lograr la rentabilidad, sin sacrificar nunca el desempeño mientras controlan los costos. Solo con este tipo de mentalidad, la industria puede seguir creciendo de manera sostenible. Este cambio no ocurrirá de la noche a la mañana, pero debe ganar más impulso ahora para mitigar el mayor riesgo de enfermedades y aprovechar completamente el potencial de esta industria.




Un modelo de economía circular ayuda a abordar tres principios: reducir los residuos, hacer circular los productos y regenerar la naturaleza.
Por: Gwénola Jan Lafage*Hoy en día, hay varias preguntas que debemos hacernos, desde cómo abordar los desafíos globales como el cambio climático, la pérdida de biodiversidad, el agotamiento de los recursos, la escasez de agua, los desechos y la contaminación, hasta cómo construir un modelo resiliente, bueno para los negocios, las personas y el planeta. El modelo de economía circular ayuda a abordar estos desafíos, mediante la aplicación de tres principios: reducir los residuos, hacer circular los productos y regenerar la naturaleza.
Symrise Aqua Feed se especializa en el desarrollo, evaluación y manufactura de ingredientes sustentables y
mejoradores de la palatabilidad, los cuales ayudan a los fabricantes de alimento para acuicultura a producir dietas de alto desempeño y alimentos con baja huella de carbono.
La empresa emplea un modelo circular para llevar los coproductos marinos a su valor más alto, apoyando a la industria a enfrentar el desafío de lograr alimentos acuícolas más sostenibles. En la Figura 1, mostramos cómo nuestras soluciones pueden crear valor para la industria de la acuicultura.

Las actividades de Symrise Aqua Feed forman parte de un modelo virtuoso. Recolectando residuos orgánicos de la industria acuícola de camarones, peces y, también, de pesquería, generando productos circulares a partir de esos residuos,
agregando valor a lo largo de la cadena de acuicultura y participando activamente en la regeneración de la naturaleza. Este ciclo de vida sustentable de los productos, viene acompañado de una baja huella de carbono.
Materia prima 100% a partir de subproductos
De acuerdo con la Organización de las Naciones Unidas para la Agricultura y la Alimentación (FAO), cerca de un tercio del total del alimento producido en el mundo se desperdicia o se pierde. Hoy en día esto parece simplemente inaceptable o impensado de continuar, dado el enorme valor de los nutrientes. Symrise Aqua Feed recolecta materias primas (copro-
ductos), como cabezas de camarón, vísceras de atún, cabezas y esqueletos de tilapia, y otros subproductos de origen marino, los cuales no son utilizados para consumo humano, y son sobrantes o productos de desecho en las plantas de procesamiento. Al mismo tiempo, estos contienen un considerable nivel de proteína, el cual era descartado.
Anualmente, Symrise Aqua Feed recolecta más de 30,000 toneladas de tales subproductos en sus tres plantas de manufactura en Costa Rica, Ecuador y Tailandia. Estas se encuentran localizadas en las cercanías de las empresas que procesan pescados y camarones, garantizando, entre otras cosas, la frescura de sus materias primas. La localización estratégica de estas plantas también ayuda a optimizar la logística y minimizar la huella de carbono asociada a su transporte.
Symrise Aqua Feed audita a todos sus proveedores y los insta a seguir los principios de responsabilidad y sustentabilidad para todas sus materias primas, siguiendo su Código de Conducta para Proveedores y su programa de certificación.
Además, al usar subproductos, se requiere una menor captura de peces silvestres que, de otro modo, se destinaría a alimentación de otros peces; reduciendo así la presión sobre los recursos marinos.
Symrise Aqua Feed procesa, transforma e incrementa el valor funcional de los subproductos, gracias al conocimiento adquirido alrededor del mundo durante las últimas dos décadas. Manejamos magistralmente el proceso de hidrolisis enzimática, apuntando al nivel más alto de estandarización para hidrolizados líquidos y en polvo, los cuales tienen múltiples beneficios a nivel de salud, nutrición y palatabilidad (Figura 2).
De igual manera, trabajamos para minimizar el impacto ambiental de nuestras actividades industriales. Para alcanzar la neutralidad de carbono para el 2030 (alcance 1 y 2), movilizamos personas, monitoreamos métricas de agua y energía, mejoramos procesos y definimos planes para los próximos años. Como ejemplo, todas las plantas de Symrise han implementado un plan de optimización operativa para reducir el consumo de energía y agua, con ganancias rápidas definidas e intercambio de mejores prácticas.
Al perseguir el objetivo de valorizar cualquier fracción de subproductos, también prestamos atención a nuestros propios residuos orgánicos. La cantidad de residuos varía del 1% al 25%, según el nivel de la fracción sólida en la mate-
ria prima. Valorizamos el material sobrante en la cadena de alimentación, tanto como sea posible, con el procesamiento posterior en harinas de pescado o camarón. Cuando el proceso de harina no es la mejor opción, entran en juego otras soluciones alternativas, como el compostaje con digestión anaerobia o bioestimulante en agricultura. Haciendo tal valorización, Symrise Aqua Feed evita el vertido o la incineración de estos subproductos. En general, siempre buscamos encontrar la valorización más alta para los subproductos de pescado y camarón.
Beneficios combinados de palatabilidad, nutrición y salud en los alimentos acuícolas
Los ingredientes usados en alimentos acuícolas, ayudan a sustituir harina de pescado a un alto nivel (1:3), mejorando la palatabilidad, estandarizando el desempeño del alimento y los peces, al mismo tiempo que reduce la variabilidad, mejorando la salud y el estado general de los peces frente a daños ambientales y a desafíos naturales de patógenos. Con una mejor digestibilidad y absorción, estos ingredientes ayudan a reducir el concepto de “Fish in” mientras maximizan el “Fish out” (FIFO). En otras palabras, al lograr una eficien-

En Symrise Aqua Feed siempre buscamos encontrar la valorización más alta para los subproductos de pescado y camarón.
Comprometida con este modelo de economía circular, Symrise Aqua Feed produce ingredientes con una baja huella de carbono y un alto impacto social positivo.

cia de dos a tres veces mayor, con la misma materia prima, Symrise Aqua Feed contribuye a reducir la presión sobre los recursos de origen marino.
En Symrise, también, estamos preocupados e intentamos crear conciencia sobre la reducción de residuos plásticos entre nuestros clientes. Para ello, hemos implementado un plan de acción con la finalidad de cambiar todos los productos líquidos a envases grandes (Flexitanques o despacho al granel), y big bags para los productos en polvo. En esta área, la planta de Tailandia se ha asociado con Second Life, una empresa social que empodera a las comunidades locales para operar proyectos socioambientales de largo plazo. En 2022, fueron recolectadas y recicladas más de 75 toneladas de desechos plásticos en ese país.
El performance zootécnico de los ingredientes formulados y fabricados por Symrise Aqua Feed es examinado y probado en Aqualis, nuestros centros de investigación y medición de performance, en asociación con científicos y granjas productivas. Al mismo tiempo que su alto desempeño está garantiza-
do, estos ingredientes también ayudan a reducir el impacto ambiental en la acuicultura.
Una alta palatabilidad, asegura un alto consumo de alimento, mientras reduce las pérdidas de este.
Con la buena nutrición, mejora la digestibilidad total de la dieta y se reduce la cantidad de alimento desechado no digerido al ambiente, mejorando el FIFO.
Genera beneficios en salud, gracias a los componentes bioactivos, mejorando la resistencia a los eventos de estrés, la salud intestinal, incrementando la supervivencia y ayudando a reducir la utilización de productos sintéticos.
Comprometida con este modelo de economía circular, Symrise Aqua Feed produce ingredientes con una baja huella de carbono y un alto impacto social positivo. Los aspectos socioculturales son cruciales para la empresa, los cuales se expresan en sus iniciativas locales para promover la salud en el trabajo, con particular atención a la seguridad en todas las operaciones.

En pocas palabras, Symrise Aqua Feed está totalmente integrada en un modelo de economía circular y muy comprometida con reducir su huella
ambiental; obteniendo el valor más alto posible del uso de los subproductos de camarón y pescado, y participando en la mejora de la cadena de valor y suministro de la acuicultura de manera sostenible a escala global.
Quality, gwenola.jan-lafage@symrise.com

ImencoAquaChile dirige sus estrategias y planes de expansión al mercado acuícola latinoamericano, ofreciendo soluciones inteligentes e innovadoras.
Por: Redacción de PAM*
Imenco es una empresa de origen noruego, establecida en 1979 como una firma de ingeniería, y durante los primeros 20 años participó en una variedad de proyectos submarinos. A lo largo de los años, Imenco ha crecido a través del desarrollo de soluciones innovadoras y mediante la adquisición de otras empresas. A finales de 2022, sumó a sus filas la división Aqua del grupo internacional de construcción naval Vard Group.
Imenco es un holding internacional que aglomera cinco áreas comerciales principales, a saber: petróleo y gas en alta mar, energías renovables en alta mar, marina naval e industrial, y acuicultura. Esta última es relativamente nueva como unidad de negocio; no obstante, se sustenta en la experiencia y trayectoria de las compañías Storvik Aqua y Vard Aqua, conociéndose con el nombre de Imenco Aqua, la cual está presente en Noruega, Escocia y Chile.
La estrategia de Imenco Aqua es tomar ventaja de las innovaciones tecnológicas y desarrollos logrados en las industrias de petróleo y gas, energías renovables, embarcaciones marinas y otros rubros, e introducirlos como soluciones inteligentes en la acuicultura.
El cambio de holding de la empresa Imenco, también aplicó para la filial Vard Aqua de Chile, dedicada a proveer equipos para la acuicultura, además de materializarse la entrada de Imenco a la salmonicultura chilena. De esta manera, Imenco Aqua Chile forma
parte del grupo Imenco, sumando otros productos a su cartera de productos clásicos para la acuicultura, entre los que destaca todo lo relativo a cámaras, tanto submarinas de inspección general, como de vigilancia.
Imenco Aqua Chile es su primera empresa en Latinoamérica, desde donde Imenco tiene planes de liderar en este mercado. El equipo de Chile (adquirido con Vard Aqua) cuenta con una experiencia de más de 20 años en el mundo acuícola, y posee una serie de productos tecnológicos y servicios relacionados con la acuicultura, la cual abarca un amplio portafolio que involucra a la casi totalidad de las empresas participantes en la industria acuícola y salmonicultura chilena. Poco a poco, ha ido ganando espacio en el mercado latinoamericano, y continúa avanzando en la ampliación de sus operaciones, a través del trato directo con sus clientes.
Imenco Aqua Chile suministra tecnologías, equipos y soluciones inteligentes a la industria acuícola, con la finalidad de procurar el bienestar, desarrollo, crecimiento y salud óptima de los peces. Asimismo, sus soluciones tecnológicas se basan en la importancia del control sobre los peces; por ejemplo, la tecnología de cámaras y de marcos de estimación de biomasa, permite a los salmonicultores observar en todo momento, con una alta calidad de imagen, cómo están los peces


y cómo crecen. Las áreas donde están concentrados los esfuerzos en Chile son oxigenación y aireación, debido a que estas soluciones se fabrican localmente.
Las soluciones inteligentes en productos se han desarrollo pensando en el usuario final y para ser sometidas a condiciones medioambientalmente desafiantes.
En el segmento de Aireación y Oxigenación, Imenco Aqua Chile comercializa difusores de oxígeno para jaulas, en diferentes formatos, como parrillas y manifold, y
La estrategia de Imenco Aqua es tomar ventaja de las innovaciones tecnológicas y desarrollos logrados en las industrias de petróleo y gas, energías renovables, embarcaciones marinas y otros rubros e introducirlos como soluciones inteligentes en la acuicultura.
cuenta con una amplia experiencia en la oxigenación como sistema permanente, por medio del difusor patentado VitaDiTM:
9 VitaDi™ Tambor de oxígeno: con varias longitudes y capacidades de manguera, adecuado para varios tamaños de jaulas y biomasas.
9 VitaDi ™ Difusor de oxígeno: es muy adecuado para mantener las condiciones óptimas de oxígeno para los peces (Figura 1).
Adicionalmente, Imenco Aqua Chile ofrece sistemas de aireación para hacer frente a las floraciones algales, en formato de cortina de burbujas o como anillos de surgencia, y con un producto llamado anillo dual (en proceso de patente) que en un mismo anillo permite inyectar aire y/u oxígeno. Cabe destacar, que esta gama de productos ha tenido una gran aceptación en la industria del cultivo de peces en Centroamérica.
En cuanto a su funcionamiento, si se tiene condiciones satisfactorias de oxígeno en la profundidad de la jaula, pero existen dificultades con el intercambio de agua en las capas superiores, el sistema de surgencia (Figura 2) eleva el agua desde el fondo de la jaula de peces y proporciona una sólida mejora de la calidad del agua en las capas superiores.

Otro producto de Imenco Aqua Chile son los alimentadores, ofreciendo una amplia gama, desde equipos sencillos hasta de los más avanzados, entre los que se encuentran los discos de alimentación para producción (DiscFeeder), Belt-Feeder de amplio uso en centros de investigación y, la nueva línea, Exact para ambos propósitos, que ofrece un control total de la alimentación por medio de un software, en su formato de alimentación individual o de robot.

9 Belt Feeder: alimentador de correa, permite una manipulación cuidadosa del alimento para peces, de utilidad para centros de investigación y desarrollo y criaderos criaderos (Figura 3).

9 Disc-Feeder: alimentador de discos, para una manipulación cuidadosa del alimento para peces en los criaderos
9 Exact Mini Feeder: minialimentador exacto, para la dosificación precisa de alimento en tanques de acuicultura. Perfecto para alimentaciones de puesta en marcha con pequeñas cantidades de alimento (Figura 4).
9 Exact Feeding Robot: robot de alimentación exacto (Figura 5), alimentación totalmente automática e inteligente. El sistema se instala fácilmente en todas las piscifactorías terrestres.





Asimismo, Imenco Aqua Chile ofrece cámaras y sensores de biomasa, productos muy importantes y probados en la industria, los cuales se basan en tecnologías desarrolladas durante largos años antes de ser lanzadas al mercado, que incorporan tanto internet como inteligencia artificial.
La empresa asesora a sus clientes en todo lo relacionado a las tecnologías y productos que comercializa, ofreciendo acuerdo de servicio con una calibración y certificación anual, que brinda una mayor previsibilidad y confiabilidad de los equipos adquiridos. Además, desarrolla actividades de divulgación como la Charla de Oxigenación en Acuicultura, impartida por el Ph.D. David Ulloa Walker, la cual fue dictada en 30 diferentes ocasiones, incluyendo empresas, universidades, instituciones de investigación y congresos.
Como una empresa de tecnología con innovaciones para las industrias del petróleo y gas, energías renovables, embarcaciones marinas y otros rubros, de cara al futuro, Imenco transformará algunos de estos desarrollos y los introducirá en la acuicultura, además de apuntalar las ya existentes.
Parte de la filosofía de Imenco Aqua Chile es invertir recursos en investigación y desarrollo (I+D) para crear nuevas soluciones y, a su vez, mejorar las ofrecidas actualmente en acuicultura y abordar nuevos desafíos. Para ello, han reforzado la I+D de nuevas versio-
nes y productos, trabajando con universidades para algunas validaciones, asesoría de expertos e inversión en un laboratorio para pruebas locales.
Imenco Aqua tiene entre sus planes lanzar nuevos equipos de alimentación, oxigenadores, estimadores de biomasa, softwares, cámaras y
nuevas mejoras a los equipos existentes. Durante el segundo semestre de 2023, Imenco Aqua presentará el nuevo estimador de biomasa y nuevas cámaras. Asimismo, se reforzará toda el área de equipos de alimentación, incluyendo discos, Belt feeder, Exact, y el robot de alimentación, junto con la integración de toda la variedad de productos relacionados con cámaras.


En lo que se refiere a infraestructura, se reforzará la fábrica en Chile, con la finalidad de procurar los mismos parámetros de calidad que las de Noruega y el Reino Unido, y expandir la producción de los nuevos productos, manteniendo la misma tecnología y estándares de calidad. En el caso de alimentadores automáticos, los modelos Belt feeder y Exact para empresas acuícolas de camarones se han comercializado exitosamente en el mercado ecuatoriano.
Utilizando la actual plataforma del grupo, la estrategia de Imenco Aqua es expandir su presencia en diferentes mercados, ofreciendo un portafolio de productos más amplio, con soluciones adecuadas a las necesidades de cada cliente. En la actualidad, se atienden diferentes segmentos que incluyen el cultivo de especies de peces como: salmones, truchas, tilapias, seriola, esturiones, pargo, cobia, entre otras.
En los últimos años, se han realizado negocios desde Chile al resto de América Latina; sin embargo, en esta fase actual de expansión, los planes son comenzar a tener mayor presencia en países como Ecuador y México, dada la importancia de esos mercados en Latinoamérica y el mundo.
Centroamérica también se encuentra entre los objetivos. Imenco Aqua Chile ha concretado ventas de sus productos en Panamá y Costa Rica, lo que ha generado un análisis detallado de este mercado y el establecimiento de planes a futuro.
En síntesis, la proyección de Imenco Aqua Chile para 2023 es trabajar arduamente para brindar soluciones a sus clientes, reforzar sus actividades de investigación y desarrollo y expandirse a nuevos mercados, garantizando el contacto permanente con clientes y usuarios para detectar áreas de oportunidad y mejora.
www.imenco.com
Jorge Flores
Gerente Comercial y Operaciones jorge.flores@imenco.com

BioRED®PlusdeIndustrialOrgánica,S.A.deC.V., es un concentrado de pigmentos de alta biodisponibilidad, el cual es insoluble en agua, sumamente estable, se integra con facilidad en el alimento balanceado y se ha usado con éxito en pruebas en acuicultura.
El producto Bio RED®Plus de Industrial Orgánica, S.A. de C.V., es un concentrado de pigmentos de alta biodisponibilidad, el cual se integra fácilmente en el alimento balanceado. Es insoluble en el agua y sumamente estable. Sus componentes principales son la luteína y la zeaxantina. Estas xantofilas pertenecen a un grupo de moléculas liposolubles conocidas con el nombre de carotenoides, que son producidos de forma natural por algunas especies de plantas, microalgas y bacterias. Algunos de ellos se elaboran de manera sintética. Los carotenoides son esenciales para la nutrición animal.
En general, los organismos no pueden sintetizar de novo los carotenoides, por lo que deben obtenerlos de su dieta, ya sea de forma directa o indirecta a partir de moléculas precursoras. Los camarones peneidos, en particular, tienen una gran capacidad metabólica para transformar precursores, como la luteína y la zeaxantina, y convertirlas en astaxantina, la cual es el carotenoide más abundante en su cuerpo y en el de otros crustáceos, encontrándose en diversos tejidos, ya sea, en forma libre o esterificada formando carotenolipoproteínas.

En la acuicultura, la astaxantina sintética es el carotenoide más empleado en las dietas para la pigmentación de especies como el salmón, las truchas y los camarones peneidos; sin embargo, tiene un costo alto. Inicialmente, el objetivo del subsidio pigmentario incluido en el alimento balanceado para el cultivo de estos grupos, se hizo con el fin de incrementar su valor en el mercado al proporcionar un color más intenso durante la cocción. No
obstante, con el desarrollo de las tecnologías de cultivo, se descubrió que su inclusión en las dietas mejora la resistencia a ciertas enfermedades y condiciones de estrés, ya que los carotenoides en general y la astaxantina en particular, son potentes antioxidantes naturales. Algunos autores consideran a la astaxantina como un estimulador de la respuesta inmune. Lo anterior se traduce en una mejor respuesta zootécnica que, a su vez, incide en un mayor rendimiento del cultivo.
En el caso del cultivo de camarón, en la década de los noventa se demostró que no era estrictamente necesario aplicar astaxantina de manera directa, en las dietas
balanceadas, para lograr un incremento de su concentración en los tejidos blancos y caparazón, ya que se comprobó que se pueden utilizar con eficiencia algunos precursores amarillos (xantofilas), los cuales son transformados en astaxantina por el metabolismo del camarón para sustentar diferentes funciones fisiológicas.
Uso de Bio RED® en la camaronicultura. Bio RED®Plus se ha usado con éxito en pruebas en acuicultura. Al igual que con otros productos elaborados por Industrial Orgánica S.A. de C.V. con base en carotenoides del cempasúchil, se ha demostrado que
al aplicarse en el alimento en concentraciones de 120 a 150 ppm, se incrementa la concentración de astaxantina en los tejidos del camarón y se mejora el rendimiento del cultivo en condiciones comerciales, tanto en ciclos desarrollados en condiciones óptimas, como en ciclos afectados por mortalidades masivas producidas por enfermedades, bajas concentraciones de oxígeno o temperaturas extremas.
Por ejemplo, en una prueba a escala comercial desarrollada recientemente, en condiciones óptimas en el norte de la costa de Sinaloa, los rendimientos en los estanques de cultivo de camarón blanco Litopenaeus vannamei tratados con Bio RED®Plus fueron mejores que en los estanques de control, el peso promedio individual final del camarón se incrementó en un 11%, la supervivencia aumentó en un 7%-10%, el factor de conversión alimenticia disminuyó en un 4%, y la producción final, en términos de kilogramos de camarón producidos por hectárea, se incrementó en un 16%, en promedio (de 1,478 a 1,710 kg/ha), después de 140-150 días de cultivo.
En otra prueba desarrollada a escala comercial en la costa norte de Sonora, se suministró alimento de alta calidad enriquecido con inmunoestimulantes y probióticos en un cultivo de L. vannamei en los estanques de control, mientras que, en otra serie de estanques, además de los probióticos e inmunoestimulantes, se adicionó Bio RED®Plus por aspersión manual sobre el alimento. En todos los estanques de prueba, se observaron mortalidades extraordinarias, debido a fluctuaciones de la temperatura y una severa vibriosis durante las semanas iniciales del cultivo. Sin embargo, al final del cultivo, se registró un incremento de la supervivencia del 15% en promedio en los estanques tratados con Bio RED®Plus, es decir, la adición de la fuente pigmentaria produjo una mejor respuesta sobre la mera aplicación de inmunoestimulantes y probióticos.
Estos resultados, en los que se observa un incremento de la respuesta zootécnica, tanto en condiciones favorables como desfavorables del cultivo asociadas a una mayor concentración de astaxantina en el cuerpo de los camarones, coinciden
con los de otras pruebas llevadas a cabo con Bio RED®Plus y, también, con los observados con otros productos naturales pigmentantes de Industrial Orgánica S.A. de C.V., incluyendo, en algunos casos, situaciones con la prevalencia de vibriosis y enfermedades de origen viral, particularmente mancha blanca.
Por la esencia lipídica de los carotenoides, su absorción en el tracto digestivo de los grupos de organismos mencionados, su transporte plasmático y su inclusión en los tejidos blancos, pasa por eventos de formación de micelas, desintegración de estas, y desesterificación y esterificación de las moléculas pigmentantes.

Además de ser transformadas en astaxantina, las xantofilas precursoras de Bio RED®Plus actúan concomitantemente, haciendo más eficiente la absorción de la astaxantina, contenida de forma natural en los insumos dietarios y la contenida de manera natural en las fuentes biológicas de los estanques, sobre todo en las primeras etapas del cultivo, una vez disparada la cadena alimenticia producida por la fertilización de los estanques.

En términos de la percepción de un mejor color para el mercado, este depende no solo del metabolismo de las fuentes dietarias de carotenoides, sino de su movilización y su concentración en los cromatóforos, producida por el tipo y el color del sustrato o por las condiciones de estrés.
En conclusión, la aplicación de Bio RED®Plus, en concentraciones de 120-150 ppm en el alimento balanceado en el cultivo del camarón blanco L.vannamei, produce una mejor respuesta zootécnica y pigmentaria en cualquier etapa del ciclo de vida y condiciones del cultivo.
Para mayor información técnica del producto, comunicarse con:
Ing. José Alberto Torres
Cel. 81-2588-9238
Email: jtorres@iosa.com.mx

El principal encuentro de pesca y acuicultura en Perú avanza a pasos agigantados, Expo Pesca & Acuiperú es la principal ventana comercial al mundo para empresas que ofertan equipos, suministros y servicios para la industria pesquera y acuícola.
Las más importantes compañías de la industria pesquera y acuícola del mundo han confirmado su presencia en la décima edición de Expo Pesca & Acuiperú, que se celebrará del 06 al 08 de septiembre en el Centro de Exposiciones Jockey en Lima, Perú. Se proyecta contar con la presencia de más de 250 exhibidores de primer nivel de Perú y países como Argentina, Brasil, Canadá, Chile, China, Colombia, Corea del Sur, Dinamarca, Ecuador, España, Estados Unidos, México, Francia y entre otros.
Oportunidad de negocios
Presentar sus productos y servicios en el evento permitirá a las empresas adentrarse en un mercado internacional cada vez más competitivo. Además, su participación contribuirá a:
9 Posicionar su marca en la industria pesquera y acuícola global.
9 Conocer y contactar a clientes potenciales.
9 Encontrar representantes y aliados comerciales.
9 Analizar a su competencia.
9 Realizar grandes negocios con clientes nacionales e internacionales.
Congreso Técnico de Pesca y Acuicultura:

Durante Expo Pesca & Acuiperú, se desarrollará un interesante programa de conferencias técnicas, el cual tiene como finalidad la actualización de los conceptos generales en la extracción, producción
y comercialización, así como dar a conocer los más recientes avances tecnológicos en el mercado internacional. Los participantes que hayan asistido de manera regular al programa, recibirán un Certificado, internacionalmente reconocido, acreditando haber culminado satisfactoriamente el Congreso Pesquero Expo Pesca & Acuiperú.
Información para exhibir
Correos: bsanchez@thaiscorp.com gdelatorre@thaiscorp.com
Teléfonos: +51 987-421-834; +51 982 508 607 ¡Participe como exhibidor en el principal encuentro pesquero, acuícola y seafood de Perú!
Este artículo es patrocinado por FERIA INTERNACIONAL EXPO PESCA & ACUIPERÚ 2023

Muchos consumidores se preocupan por conocer el origen y las certificaciones de lo que consumen. Por ello, los productos de la acuicultura deben proveer los más sólidos estándares de autenticidad, que se apliquen regularmente en toda la cadena de valor y ayuden a prevenir la ocurrencia de eventos que representen algún tipo de riesgo.
Por: Yahira Piedrahita*Las normas alimentarias y el comercio van de la mano para garantizar alimentos seguros, nutritivos y suficientes para una población mundial en crecimiento. En la actualidad, es difícil imaginar el comercio de alimentos sin estándares que brinden confianza a los consumidores sobre la seguridad, calidad y autenticidad de lo que comen.

Cada gobierno es responsable de garantizar que la población de su país acceda a alimentos seguros; por ello, todos los países tienen leyes que incluyen aspectos de soberanía y seguridad alimentaria, así como aspectos de inocuidad y normas técnicas relativas a calidad de los alimentos. A pesar de todos los matices positivos de la legislación alimentaria, adentrándonos en el comercio internacional, si cada gobierno aplica diferentes normas alimentarias, el comercio es más costoso y es más difícil garantizar que los alimentos sean seguros y cumplan con las expectativas de los consumidores.
La Organización Mundial de Comercio (OMC), es la única organización mundial con el mandato de hacer frente a las reglas del comercio entre las naciones. Los Estados Miembros de la OMC se unen para negociar estas reglas,
que toman la forma de acuerdos comerciales adoptados por consenso.
Un punto clave respecto al comercio internacional de alimentos, fue la llegada de los acuerdos llamados MSF y OTC. El acuerdo sobre la Aplicación de Medidas Sanitarias y Fitosanitarias (acuerdo MSF) se refiere a la aplicación de las normas de inocuidad de los alimentos, así como la sanidad animal y vegetal; mientras que el acuerdo sobre los Obstáculos Técnicos al Comercio (acuerdo OTC) tiene por objeto garantizar que los reglamentos técnicos, las normas y los procedimientos de evaluación de la conformidad no sean discriminatorios y no creen obstáculos innecesarios al comercio (las llamadas medidas paraarancelarias).
El comercio mundial de alimentos se rige principalmente por las directrices que emanan del Codex Alimentarius, que consiste en una colección de normas alimentarias aceptadas internacionalmente y presentadas de modo uniforme. El objeto, de estas normas alimentarias, es proteger la salud del consumidor y asegurar la aplicación de prácticas equitativas en el comercio de los alimentos. Incluye también disposiciones de natura-
lo inevitable en el comercio mundial de los productos de




































































































































































































































































































Hace poco, en un grupo de discusión, se tocó el tema acerca de qué falta para consolidar la maricultura a escala global. Muchos coincidimos en que el futuro, no solo de la acuicultura, sino de la alimentación mundial, está en los océanos. Al respecto, me gustaría destacar algunos puntos clave.
Hace poco, en un grupo de discusión, se tocó el tema acerca de qué falta para consolidar la maricultura a escala global. En el occidente, además del salmón en Noruega y Chile, así como la lubina y la dorada en el Mediterráneo, no hay ejemplos recientes del desarrollo de alguna industria, de
peces marinos, basada en acuicultura de aguas abiertas. En Asia, en contraste, existe un gran número de especies que se cultivan, pero casi todas en aguas protegidas, con sistemas mucho más rústicos y, en muchos casos, afectando ya el medio ambiente que las rodea porque, en la mayoría de las situaciones, se está trabajando en los

límites de la capacidad de carga de los sistemas.
Muchos coincidimos en que el futuro, no solo de la acuicultura, sino de la alimentación mundial, está en los océanos. Lo anterior, debido a que se disminuye la presión de las zonas arables del planeta, en franco declive, para la producción de alimentos. Además,

 Por: Alejandro Godoy*
Por: Alejandro Godoy*
El consumo de proteínas ha cambiado en los últimos tres años de manera disruptiva, de tal manera que los acontecimientos, como el COVID-19 y la inflación, han presionado a los consumidores a cambiar de proteína animal en sus dietas, buscando mejor opción y relación costo-beneficio.
El consumo de proteínas ha cambiado en los últimos tres años de manera disruptiva, de tal manera que los acontecimientos, como el COVID-19 y la inflación, han presionado a los consumidores a cambiar de proteína animal en sus dietas, buscando mejor opción y relación costo-beneficio.
En Estados Unidos, estos cambios de hábitos los podemos observar en la Tabla 1, comparando entre 2019 y 2023, la carne de cerdo es la proteína cuyo consumo más disminuye, en un 3%. La segunda proteína con disminución de consumo es la carne de res, con un 2%, mientras que el pollo crece un 5%. Los alimentos del mar (seafood) o pescado y marisco
se presentan como la proteína con mayor crecimiento, con un 13%.
México también cambia sus hábitos en consumo de proteínas, en particular, presionado por factores inflacionarios. Como podemos observar en la Tabla 2 de consumo per cápita, expresada en kilogramos, la proteína de res obtuvo menor crecimiento con un 1%, seguido del pollo con un 6%, el cerdo con un 11% y pescado y marisco con un 12%.

Según mi experiencia, y basado en estudios del consumidor, este comportamiento de cambio de proteínas se debe principalmente al precio, cultura culinaria, tiempo de preparación, disponibilidad, y dieta saludable; cada una de las cuales describo a continuación:

Precios: en el caso del precio podemos identificar que los pescados y mariscos, tanto en Estado Unidos como en México, no han sufrido grandes aumentos, comparados con las otras proteínas. La inflación generó nuevas estrategias para los productores, al vender porciones más pequeños o en empaques menores, para disimular el aumento en precio, así como el uso de marcas genéricas.
Cultura culinaria: podemos identificar que el crecimiento de los restaurantes de preparación de pescado y marisco en México, según el Instituto Nacional de Estadística y Geografía (INEGI), han aumentado un 23% entre 2019 y 2023, en comparación con los

El potencial de financiamiento de la industria acuícola por medio de créditos de carbono aún se encuentra en proceso de definición. Sin embargo, en algunos casos específicos, esto ya se ha convertido en una realidad.
El cambio climático es un fenómeno ampliamente conocido y sus consecuencias se sienten en todo el mundo, a menudo con efectos catastróficos. Es causado por el calentamiento global que, a su vez, se origina en el “efecto invernadero”. Este efecto es producido por la acumulación de ciertos gases en la atmósfera, los cuales impiden que el calor recibido del sol sea irradiado de regreso al espacio, generando un aumento en la temperatura global. Los principales gases responsables de esto son el dióxido de carbono (CO2), el metano (CH4) y el óxido nitroso (N2O). Entre ellos, el CO2 es el más importante debido a su alta concentración y permanencia en la atmósfera.
En respuesta a esta situación, se están realizando esfuerzos a escala mundial para reducir la producción de CO2 y fomentar actividades y proyectos que absorban este gas y lo retiren de la atmósfera. Surgieron así los bonos y créditos de carbono, que se comercializan en los Mercados de Carbono, plataformas digitales especializadas para este fin. Los bonos son instrumentos financieros generados por gobiernos nacionales o grandes empresas, mientras que los créditos pueden ser generados por cualquier empresa o proyecto que cumpla con los requisitos necesarios. En este artículo nos enfocaremos en los créditos, que son los más aplicables a nuestro sector.
Es importante destacar que los créditos de carbono pueden ser una oportunidad para la acuicultura, ya que esta actividad puede contribuir
a la reducción de emisiones y al secuestro de carbono a través de prácticas sostenibles y la conservación de ecosistemas marinos. Sin embargo, es necesario definir de manera más precisa cómo se puede aplicar el concepto de carbono azul en el contexto de la acuicultura y cómo se pueden generar créditos de carbono, específicamente, para este sector.

Un “crédito de carbono” es una unidad de medida equivalente a una tonelada de CO2, y es lo que se compra y vende en los mercados de carbono. El funcionamiento de estos mercados es un concepto no muy complicado. Por un lado, existen empresas que, a pesar de haber hecho todos los esfuerzos necesarios y económicamente viables, siguen generando una cantidad de CO2 mayor de lo permitido por las regulaciones. Por ejemplo, pueden tener autorizadas 500 toneladas de CO2, pero producen 600 toneladas.
Por otro lado, existen empresas y proyectos que, debido a su naturaleza, capturan y almacenan CO2, ya sea a través de la reforestación u otros métodos, como la captura directa del aire. Estas acciones

deben ser certificadas por organismos autorizados. Si una de estas empresas captura y almacena 100 toneladas de CO2, puede generar 100 créditos de carbono. Estos créditos pueden ser comprados por la empresa mencionada anteriormente, que excedía su límite en 100 toneladas, permitiéndole cumplir con las regulaciones establecidas.
De esta manera, los créditos de carbono facilitan el equilibrio entre las emisiones excesivas de unas empresas y la capacidad de absorción de CO2 de otras. Al adquirir créditos de carbono, las empresas que emiten más CO2 del permitido pueden compensar sus emisiones al apoyar proyectos y actividades que reduzcan las emisiones o capturen CO2. Esto fomenta la reducción global de emisiones y ayuda a mitigar el cambio climático.
Los precios de los créditos de carbono pueden variar según el país de emisión y factores como la oferta y la demanda. A manera de referencia, en Estados Unidos en este año 2023, el precio oscila entre US$40 y US$80 por crédito. En México, el precio actual es de solo US$10 debido a que recién este año se imple-
¿Qué es y cuál es su potencial para el financiamiento de la acuicultura?
 Por: Stephen G. Newman*
Por: Stephen G. Newman*
A medida que evoluciona la ciencia de la acuicultura, aumenta la tendencia a pasar de modelos de producción no basados en la ciencia a modelos basados en la ciencia. La producción sostenible depende de la reproducibilidad, así como de la capacidad de garantizar una producción constante ante el aumento de los costos y los retos del mercado. Sin embargo, no siempre la tecnificación es la respuesta.
Amedida que evoluciona la ciencia de la acuicultura, aumenta la tendencia a pasar de modelos de producción no basados en la ciencia a modelos basados en la ciencia. La producción sostenible depende de la reproducibilidad, así
como de la capacidad de garantizar una producción constante ante el aumento de los costos y los retos del mercado. En el sudeste asiático, la escasez de tierras y la alta densidad de población han configurado la fisonomía actual de la cría de camarones. Las granjas suelen ser

pequeñas, con estanques o tanques revestidos de plástico con sumideros u otros medios para eliminar fácilmente los residuos acumulados. La aireación intensa es la norma, al igual que la alta densidad de población. En América, las granjas suelen ser mucho más grandes,

¿Por qué la “tecnificación” es un arma de doble filo?

9 Alimentadores automáticos: un gran control del consumo de alimento garantiza menos desperdicio y una mayor consistencia.
9 Bioremediación: uso de especies de Bacillus para digerir la materia orgánica que se acumula como subproducto natural del proceso de producción.
Ecuador optó hace algunos años por no controlar la presencia de patógenos, y permitir que todos sus organismos estuvieran expuestos a lo que hubiera en el entorno. Algunos especulan que este enfoque exposición a patógenos (All
pathogen exposure, APE) también forma parte de este éxito. Por desgracia, dado que el uso de la tecnología para reducir el estrés y aumentar la productividad es aparentemente esencial para el crecimiento continuo de la industria, la presencia de una infinidad de patógenos que reduce las posibilidades de cosechas exitosas asegura que la recuperación de los costos adicionales de estos enfoques puede ser un reto en el mejor de los casos y no alcanzable en el peor.
Actualmente, es evidente el éxito de Ecuador, a pesar de los problemas de sanidad animal, siguen siendo capaces de producir
organismos por menos dinero que la mayoría de sus competidores del sudeste asiático. Cuando las enfermedades reducen la eficiencia, el impacto puede ser proporcional a las inversiones globales en tecnología. Los estanques pequeños, revestidos, con altos índices de aireación (lo que equivale a elevados costos por consumo eléctrico) y con cientos de animales por m2 tienen poca flexibilidad en cuanto a la producción para garantizar una rentabilidad constante. Los estanques más grandes, sin revestimiento, con menos de 30 m2 de densidad de población, aireación, comederos automáticos, etc., tienen menos

Cuando las enfermedades reducen la eficiencia, el impacto puede ser proporcional a las inversiones globales en tecnología.
 Por: Ing. Lilia Marin Martinez* y QFB. Juan Pablo Zaragoza Gonzalez.
Por: Ing. Lilia Marin Martinez* y QFB. Juan Pablo Zaragoza Gonzalez.

La observación microscópica se basa en la capacidad del microscopista para reconocer los elementos que forman parte del origen puro de los diversos ingredientes, diferenciándolos de lo contaminantes o ingredientes indeseados.
Para realizar microscopia, en ingrediente y alimentos balanceados, es necesario usar un estereoscopio de bajo aumento (8 - 50x) acompañada a veces por el uso de spot tests (reacciones químicas) para la identificación de partículas, minerales, vitaminas y antibióticos.
La observación microscópica se basa en la capacidad del microscopista para reconocer los elementos que forman parte del origen puro de los diversos ingredientes, diferenciándolos de lo contaminantes o ingredientes indeseados, los cuales se identifican a través de su aspecto, color, tamaño de partículas, suavidad, dureza, textura, olor, etc.
Por su parte, cuando los ingredientes se encuentran muy molidos, o se requiere una confirmación, la identificación se realiza de acuerdo a la estructura celular o histológica, a través del microscopio compuesto (50 - 500x). Al visualizarse particularmente la distribución y estado físico de los almidones y de la grasa, se logra su identificación.

Para realizar la microscopía se deben utilizar juegos de tamices de diferentes mallas, balanza electrónica de precisión, mortero, colección de referencia de ingredientes (muestras patrón), pinzas, papel de filtro, probetas y otros accesorios.
El paso preliminar es proceder a la técnica de flotación para ingredientes AOAC 970.09 o del ingrediente de elevado porcentaje de grasa, a los efectos de poder observar nítidamente los componentes de la muestra. Para ello, se utilizan
solventes tales como tetracloruro de carbono o cloroformo. En los alimentos terminados o ingredientes con escaso porcentaje de grasa, se procede directamente a una técnica de tamizado, para lo cual se utilizan tamices USA STANDARD TESTING
SIEVE No. 10, 20, 30 y 40. Se examinan primero las fracciones de mayor tamaño, reconociendo ingredientes normales e indeseables. Se continúa con las fracciones más finas corroborando lo observado, si hubiere presencia de contaminantes molido
fino. Prácticamente todas las mate rias primas contienen fibras, tallos, huesos u otros componentes de aspecto característico que, por lo general, están contenidos en cantida des pequeñas, pero apreciables, que ayudan en gran medida a identificar la muestra; algunos cereales conser van ciertas estructuras físicas que ayudan a interpretar la observación.

El uso del estereoscopio en el control de la calidad de las harinas de carne, permite en forma rápida reconocer la presencia de elementos no deseados, definir aproximada mente su valor proteico y su perfil de digestibilidad.
En la técnica de flotación la Fracción Mineral (pesada) se pueden observar fragmentos óseos, espinas, conchilla, sales y fosfatos y en la de Fracción Orgánica (Media y livia na) es posible identificar produc tos vegetales, carne, gelatina, pelo, pluma, asta, pezuña, pico, sangre, plasma, leche y urea.
Las astas y pezuñas presentes, en cantidades elevadas, se las con sideran elementos indeseables por su baja digestibilidad. Las partículas irregulares son duras y fibrosas. Pueden ser blancas, grises y hasta
diente o alimento, puede deberse al agregado de ingredientes de alto valor en nitrógeno no proteico, como también a la presencia de malezas, cuero, etc. El perjuicio que esto trae es el desbalance de aminoácidos y la posible variación en la digestibilidad del alimento. La adulteración de un alimento puede definirse como la modificación intencional de una materia prima y su posterior comer-
Las referencias y fuentes consultadas por el autor en la elaboración de este artículo están disponibles bajo petición
*Estudió Ingeniería Química en la Universidad de Guadalajara, con especialidad en Nutrición, Producción de Alimentos para Mascotas y Acuicultura por T&M. Ha sido Jefe de Control de Calidad y Producción en Aceiteras y en Empresas de Alimentos Balanceados. Es Consultora Internacional y Nacional en Empresas de Productos Marinos, Aceites y Harinas de Pescado, Plantas de Rendimiento de subproductos de origen animal, entre otros. CEO de Proteínas Marinas y Agropecuarias S.A. de C.V. (PROTMAGRO) y de Marín Consultores
 Por: Dr. David Celdrán Sabater *
Por: Dr. David Celdrán Sabater *

La tecnología simbiótica Bioaquafloc , como concepto innovador de acuicultura regenerativa y economía circular, tiene el objetivo de reciclar el nitrógeno almacenado en el agua mediante el uso de fermento. Con el fin de profundizar en el tema, este artículo se centra en explicar porqué el fermento de salvado es una fuente principal de carbono y su aporte en el control de las relaciones C:N bajo esta tecnología, para el buen crecimiento de la especie cultivada.
El nitrógeno amoniacal total (TAN) es uno de los componentes de mayor toxicidad para los animales, producto de su metabolismo. En el agua, se encuentra en dos formas químicas denominadas amonio ionizado o amonio (NH4+) y amonio no ionizado o amoniaco (NH3); es esta última, la forma más tóxica en concentraciones altas de pH y temperatura (Anthonisen et al., 1976). En los sistemas de acuicultura intensiva, la acumulación de la forma tóxica en el agua suele ser el segundo factor limitante para aumentar los niveles de producción, después del oxígeno disuelto (Ebeling et al., 2006).

A niveles tóxicos, los organismos acuáticos son incapaces de extraer la energía necesaria de su alimentación. Por ejemplo, Burkhalter y Kaya (1977) reportaron retrasos en el crecimiento de truchas sometidas a concentraciones de 0.06 ppm NH3 y Chen et al. (2020), describen inhibición en el crecimiento de tilapias sometidas a concentraciones por encima de 0.5 ppm por un tiempo prolongado de 96 h. Este resultado es producto de la reducción en la capacidad de captación de oxígeno por daños del epitelio



ALIMENTOS BALANCEADOS
GBPO GAM.........................SEGUNDA DE FORROS
Contacto: Adriana Armijo
Tel: +668 817 5471
E-mail: ventaspacifco@gbpo.com.mx www.gbpo.com.mx
MEGASUPPLY
47
Centroamérica, EE.UU., Europa, Sudamérica, Asia y Medio Oriente
Tel: +1 305 381 0210
E-mail: orders@megasupply.net www.megasupply.net
NATIONAL RENDERERS ASSOCIATION, INC CONTRAPORTADA Oficina para Latinoamérica: Sierra Candela 111 Oficina 501. Lomas de Chapultepec
C.P. 11000 CDMX Contacto: Luz María Cano.
Tel: (55) 55 5980 6080
E-mail: nramex@nralatinamerica.org
SKRETTING...............................................................1
Km 6.5 vía Durán-Tambo, Durán, Ecuador
Contacto: Piero Botteri
Tel: +593 9693 78133
E-mail: piero.botteri@skretting.com https://www.skretting.com/es-EC/
VITAPRO / NICOVITA...............................................37
Av. 28 de Julio 1150, Miraflores Lima, Perú.
Contacto: María Alejandra Rivera Cárdenas
Cel: +51 996 479 973
E-mail: mriveraca@vitapro.com.pe www.vitapro.com.pe
ZEIGLER BROS, INC...............................................57 400 Gardners, Station RD, Gardners, PA. 17324, EE.UU. Contacto: Susan Thompson
Tel: 717 677 6181
E-mail: sales@zeiglerfeed.com www.zeiglerfeed.com
ANTIBIÓTICOS, PROBIÓTICOS Y ADITIVOS PARA ALIMENTOS MEGASUPPLY 47
Centroamérica, EE.UU., Europa, Sudamérica, Asia y Medio Oriente
Tel: +1 305 381 0210
E-mail: orders@megasupply.net www.megasupply.net
PHODÉ........................................................................5
E- mail: phode@phode.com www.phode.com
PRILABSA INTERNATIONAL CORP 19 2970 W. 84 St. Bay #1, Hialeah, FL. 33018, EE.UU. Contacto: Roberto Ribas.
Tel: 305 822 8201, 305 822 8211
E-mail: rribas@prilabsa.com www.prilabsa.com
COSECHADORAS, MAQUINARIA Y EQUIPO PARA FABRICACIÓN DE ALIMENTOS EXTRUTECH 89
343 W. Hwy 24, Downs, KS 67437, EE.UU.
Contacto: Judy Long.
Tel: 785 454 3383, 785 284 2153, 52 2955 2574
E-mail: extru-techinc@extru-techinc.com, osvaldom@extru-techinc.com
www.extru-techinc.com
IMENCO AQUA ..65
Ruta 5 Sur, Km 1025 Mod. 15 A. Puerto Montt, Chile.
Contacto: David Ulloa, Gerente General.
E-mail: david.ulloa@imenco.com
Contacto: Jorge Flores, Gerente de Ventas y Operaciones.
E-mail: jorge.flores@imenco.com
www.imenco.com
EQUIPOS DE AIREACIÓN, BOMBEO, FILTROS, MOBILIARIO PARA LABORATORIO E INSTRUMENTOS DE MEDICIÓN
SUN ASIA AERATION INT´L CO., LTD.....................9
15f, 7, Ssu-wei 4 road, Ling-ya District, Kaohsiung, 82047 Táiwan R.O.C.
Contacto: Ema Ma.
Tel: 886 7537 0017, 886 7537 0016
E-mail: pioneer.tw@msa.hinet.net
www.pioneer-tw.com
EVENTOS Y EXPOSICIONES
2023 AFRAQ AQUACULTURE AFRICA..................93
13 al 16 de Noviembre, 2023. Lusaka, Zambia
T: (+1) 760 751 5005
Fax: (+1) 760 751 5003
E: worldaqua@was.org
W: www.was.org
AQUASUR................................................................77
La cena de la Industria Acuícola.
10 de Agosto, 2023. Hotel Enjoy Puerto Varas.
W: www.aqua-sur.cl
AQUACULTURE AMERICA 2023...........................93

18 al 21 de Febrero, 2024. San Antonio Marriott
Rivercenter. San Antonio, Texas.
Tel: +1 760 751 5005
E-mail: worldaqua@was.org
www.was.org
AQUA EXPO EL ORO 2023....TERCERA DE FORROS
11 al 13 de julio, 2023. Hotel Oro Verde. Machala, Ecuador.
Tel: (+593) 99 597 2885
E-mail: aquaexpoec@cna-ecuador.com
AQUA EXPO GUAYAQUIL 2023..............................33
23 al 26 de octubre, 2023
Centro de Convenciones. Guayaquil, Ecuador.
Tel: (+593) 99 597 2885
E-mail: gnivelo@cna-ecuador.com
ASIAN-PACIFIC AQUACULTURE 2024..................93
11 al 14 de Junio, 2024. Surabaya, Indonesia
T: (+1) 760 751 5005
Fax: (+1) 760 751 5003
E: worldaqua@was.org
W: www.was.org
BLUE FOOD/GREEN SOLUTIONS AQUA 2024.....93
26 al 30 de Agosto, 2024. Copenhagen, Dinamarca
T: (+1) 760 751 5005
Fax: (+1) 760 751 5003
E: worldaqua@was.org
W: www.was.org, www.aquaeas.org
FERIA INTERNACIONAL EXPO PESCA & ACUIPERU & SEAFOOD LIMA. 73
6 al 8 de Septiembre, 2023. Lima, Perú.
E-mail: thais@thaiscorp.com
T: (511) 989-177-352
https://www.seafoodlima.com/
SERVICIOS DE INFORMACIÓN
Panorama Acuícola Magazine
Empresarios No. #135 Int. Piso 7 Oficina 723
Col. Puerta de Hierro, C.P.45116. Zapopan, Jal. México. Cruza con las calles Av. Paseo Royal Country y Blvrd. Puerta de Hierro
Tels: +52 (33) 8000 0578
Contacto 1: Suscripciones
E-mail: suscripciones@panoramaacuicola.com
Tel: +52 (33) 8000 0629 y (33) 8000 0653
Contacto 2: ventas y mercadotecnia
E-mail: crm@dpinternationalinc.com
www.panoramaacuicola.com
THE AQUA CULTURE EXPO
Agosto 3-5, 2003
Greater Noida, Uttar Pradesh, India
T: +91 74199-93001, +91 74199-93004
E: info@theaquacultureexpo.com
W: https://theaquacultureexpo.com/
SHRIMP AQUACULTURE: REGENERATION
Agosto 16-17, 2023.
Bali, Indonesia
T: (65) 6327 8825/ F: (65) 6223 7314
E: conference@tarsaquaculture.com
W: http://tarsaquaculture.com
AQUA NOR
Agosto 22-24, 2023
Trondheim, Noruega
T: +47 73 56 86 40
E: post@nor-fishing.no
W: https://aquanor.no
WORLD SEAFOOD SHANGHÁI
Agosto 23-25, 2023
Shanghai, China
T: +86-21-61276585
E: weishijun@ite-gehua.com
W: https://www.worldseafoodshanghai.com/
JOINT INTERNATIONAL CONGRESS ON ANIMAL SCIENCE
Coorganizado por: European Federation of Animal Science (EAAP), World Association for Animal production (WAAP) and Interbull
Agosto 26-Sept. 1, 2023
Lyon, Francia
T: +33 (0)6 25 64 53 17
E: Información general: infoeaap2023@wearemci. com
Registo: registrationeaap2023@wearemci.com
Oportunidades de patrocinio y exhibición: jean-marc. perez0000@orange.fr
W: https://eaap2023.org/
SEPTIEMBRE 2023
GLOBAL SHRIMP FORUM
Sept. 5-7, 2023
Utrecht, Países Bajos
W: https://www.shrimp-forum.com/
SEAGRICULTURE USA 2023
Sept, 6-7, 2023
Portland, ME, EEUU
T: +31 85 401 73 97
E: info@dlg-benelux.com
W: https://seagriculture-usa.com/
EXPOPESCA ACUIPERÚ/SEAFOOD LIMA
Sept. 6-8, 2023
Lima, Perú
T: (511) 989-177-352
E: thais@thaiscorp.com
W: https://www.seafoodlima.com/
SEAFOOD EXPO ASIA 2023
Sept. 11-13, 2023
Singapur
T: +1 207-842-5517
E: sales-asia@seafoodexpo.com
W: https://www.seafoodexpo.com/asia/
BALANCED DIVERSITY IN AQUACULTURE

DEVELOPMENT
Sept. 18-21, 2023
Vienna, Austria
T: +1 760 751 5003
E: worldaqua@was.org
W: www.aquaeas.org
WORLD SEAFOOD CONGRESS 2023
En asociación con International Conference on Molluscan Shellfish Safety
Sept. 25-27, 2023
Peniche, Portugal
E: president@iafi.net and susana.mendes@ipleiria. pt
W: https://www.wsc2023.com/
AQUACULTURE INNOVATION CONFERENCE, INNAQUA CHILE 2023
Sept. 26-28, 2023
Puerto Varas, Chile
E: innaqua@clubinnovacionacuicola.cl
W: www.innaquaconference.cl
11º CONGRESO INTERNACIONAL CONXEMARFAO
Oct. 2, 2023
Vigo, España
T: +34 986 433 351
E: conxemar@conxemar.com
W: https://www.conxemar.com/es/congreso-2023/
AQUAEXPO GUAYAQUIL
Oct. 23-26, 2023
Guayaquil, Ecuador
T: (+593) 99 597-2885
E: gnivelo@cna-ecuador.com
W: www.aquaexpo.com.ec
CHINA FISHERIES AND SEAFOOD EXPO
Oct. 25-27, 2023
Hongdao, China
T: +86 10 58672620
E: info@seafarechina.com
W: www.chinaseafoodexpo.com
AQUAEX INDIA
Noviembre 2-4, 2023
Bhimavaram, AP, India
T: +91 98480 33333
E: mail@aquaexindia.com
W: https://aquaexindia.com/
AQUACULTURE TAIWAN EXPO & FORUM
Nov 1-3, 2023
Taipei, Taiwan
T: +886 2 2738 3898
E: aat-tw@ubm.com
W: https://www.cantonfair.net/event/1683-aquaculture-taiwan-expo-forum
BUSAN INTERNATIONAL SEAFOOD AND FISHERIES EXPO (BIFE)
Nov. 1-3, 2023
Busan, Corea
T: +82-51-740-7518,7519
E: bisfe@bexco.co.kr
W: https://www.bisfe.com:456/eng/
2023 AFRAQ AQUACULTURE AFRICA
Nov. 13-16, 2023
Lusaka, Zambia
T: (+1) 760 751 5005
Fax: (+1) 760 751 5003
E: worldaqua@was.org
W: www.was.org
ALGAEUROPE 2023
Dic 12-15, 2023
Praga, República Checa
T: +31 85 401 73 97
E: info@dlg-benelux.com
W: https://algaeurope.org/
La acuicultura en América Latina enfrenta importantes desafíos, que han dificultado su desarrollo. Aprovechar el potencial de esta industria y así enfrentar la creciente demanda de productos acuáticos, solo será posible mediante un enfoque integral y sostenible.
Por: Artemia SalinasAunque la acuicultura ha experimentado un auge global en las últimas décadas, lamentablemente, América Latina no ha logrado aprovechar todo su potencial en este sector. A pesar de contar con una rica biodiversidad acuática, extensas costas y potencial para satisfacer la creciente demanda de productos pesqueros y acuícolas, la región enfrenta diversos obstáculos que han llevado a un mesurado crecimiento de la acuicultura.
que frenan el desarrollo
9 Falta de inversión y apoyo gubernamental

Uno de los principales obstáculos para el desarrollo de la acuicultura en América Latina es la falta de inversión, tanto pública como privada. Aunque algunos países han reconocido el potencial del sector, el apoyo financiero y las políticas adecuadas para promover su crecimiento han sido insuficientes.
9 Barreras regulatorias y burocráticas
La complejidad de los trámites administrativos y la falta de claridad en las regulaciones pueden desincentivar la inversión en la acuicultura. Los procesos lentos y engorrosos dificultan el establecimiento y la expansión de granjas acuícolas.
9 Problemas ambientales y sanitarios
La acuicultura puede tener un impacto significativo en el medio ambiente, si no se maneja de manera responsable. La contaminación de las aguas, la propagación de enfermedades y la introducción de especies invasoras son desafíos que deben abordarse adecuadamente.
9 Falta de investigación y desarrollo tecnológico
La innovación y la adopción de tecnologías avanzadas son fun -
damentales para mejorar la eficiencia y la sostenibilidad en la acuicultura. La falta de inversión en investigación y desarrollo ha llevado a un estancamiento en la mejora de las prácticas y la productividad.
9 Competencia con la pesca extractiva
En muchos países de la región, la pesca extractiva sigue siendo una actividad económica importante. La competencia con la acuicultura, a menudo vista como una amenaza por los pescadores tradicionales, ha generado conflictos y resistencia al desarrollo del sector acuícola.
Desafíos a enfrentar
9 Promover la inversión y el apoyo gubernamental Es esencial que los gobiernos de América Latina reconozcan la importancia estratégica de la acuicultura y fomenten la inversión, tanto pública como privada en el sector. Esto implica creación de incentivos fiscales, líneas de crédito favorables e implementación de políticas que faciliten la creación y el crecimiento de empresas acuícolas.
9 Mejorar la regulación y la gobernanza
Se requiere una revisión y simplificación de los marcos regulatorios relacionados con la acuicultura. La creación de regulaciones claras, basadas en evidencia científica y con una perspectiva de sostenibilidad, es fundamental para garantizar un desarrollo responsable del sector.
9 Impulsar la investigación y la innovación
La inversión en investigación y desarrollo tecnológico es esen-
cial para mejorar las prácticas acuícolas y enfrentar los desafíos ambientales y sanitarios. La promoción de programas de capacitación y asistencia técnica para los productores también puede aumentar la productividad y la competitividad del sector.
9 Promover la sostenibilidad y la responsabilidad social
La acuicultura debe abordar las preocupaciones ambientales y sociales. La adopción de prácticas sostenibles, la gestión adecuada de residuos y el respeto a las comunidades locales son aspectos clave para ganar aceptación y apoyo en la región.
9 Fortalecer la cooperación regional
La cooperación y el intercambio de conocimientos entre países de América Latina, pueden ser beneficiosos para el desarrollo de la acuicultura en la región. Compartir experiencias exitosas y enfrentar desafíos comunes, de manera conjunta, pueden impulsar el crecimiento del sector.
La acuicultura en América Latina enfrenta importantes desafíos que han dificultado su desarrollo. Para aprovechar el potencial de esta industria y enfrentar la creciente demanda de productos acuáticos, es necesario que los gobiernos de la región impulsen políticas de apoyo, promuevan la inversión, mejoren la regulación, fomenten la investigación y la innovación, y fortalezcan la cooperación regional. Solo mediante un enfoque integral y sostenible, la acuicultura en América Latina podrá desplegar su verdadero potencial y convertirse en un motor de desarrollo económico y social para la región.
